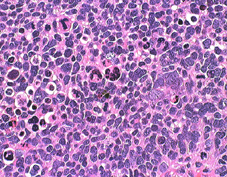

髄芽腫 medulloblastoma
- 日本での髄芽腫の年間発生例は50例くらいですから珍しいものです
- 出生数の減少に比例して,発生数が減少しています
- 乳児から幼い子供たち(中央値5歳)の小脳にできます
- 悪性腫瘍ですが,治る見込みは十分あります
- 頭痛や嘔吐,歩行時のふらつきが初発症状です
- とても早く大きくなり急に症状が進行することがあります
- 髄液の出口(第4脳室)をふさぐために頭の中に水がたまってしまいます
- 水頭症というのですが,頭痛が急激に悪化して嘔吐します
- ぐったりして意識が悪くなることがあります
- そのために緊急入院したり,臨時手術を受ける子どもが多いです
- 小脳にできるのですが,髄液にのって脳とか脊髄に転移(播種 はしゅ)します
- 髄芽腫の子どもたちの死亡原因は播種です
- ですから,治療の主目的は播種を防ぐことになります
- 播種転移のありなしで,病期 M0, M3に分類します
- 手術してから,放射線治療と化学療法(制がん剤)をします
- 手術で撒き散らした腫瘍細胞からの転移を手術誘発播種と言います
- 術後播種を防ぐために,手術後の化学療法と放射線治療は3週間以内にスタートします
- 全ての症例を対象にすれば現在でも死亡率は30-40%くらいです
- 3歳未満の患児の死亡率は高いです
病理診断は,2021年にWHOの4つの新分類がでましたが,世界中で大混乱中
- WNT activated
ウィングレス活性型,免疫組織染色で DKK1 (WNT)
- SHH activated and TP53 wildtype
ソーニックヘッジホッグ活性型,TP53遺伝子野生型
- SHH activated and TP53 mutant
ソーニックヘッジホッグ活性型,TP53遺伝子変異型
- non-WNT/non-SHH
ウィングレスでもソーニックヘッジホッグでもないもの
臨床知見と臨床医の経験値が生物学の進歩と混乱に追いついていません
- 治療法は,臨床所見・組織診断・分子診断を組み合わせて,低リスク群,標準リスク群,高リスク群の3つに分けて選択します
- 低リスク群は10%,標準リスク群は50-60%,高リスク群は30-40%くらいの頻度です
- ウィングレスの中でもDNMBタイプでは放射線治療をしなくても治ることがわかってきました
- でもその遺伝子診断をまって数週間も治療待機していると,他のタイプでは致命的な腫瘍増悪が生じてしまうことがあります
- 逆に,non-WNT/non-SHH(グループ3)は,進行が早く高率に髄液播種をしますから,死亡割合が最も高いです
- 遺伝子診断と中央病理診断は急がないと,患児を救うという観点からは意味がありません,学問的興味のために中央病理診断をしているわけではないからです
- 結果的には,個々の子供で異なる治療方法を考えるという「テイラーメイド」の方向性にあります,従来の多くの患児を一定の方針で治療するに「標準治療」とは逆行する考えです
髄芽腫のできる場所
赤く塗ってあるのが髄芽腫の最も多い場所です。小脳虫部から発生して第4脳室を埋めるように大きくなります。前の方にある脳幹部を圧迫しますが,多くの場合は脳幹部に浸潤(入り込むこと)しません。発生部位は,小脳虫部が8割くらい,小脳半球が2割くらいです。小脳,脳幹部,脳室の説明はここをクリックすると詳しく出ます。
診断は
- MRIで診断します
- 境界がはっきりした腫瘍です,くりんとしています
- ガドリニウム造影剤で白く映ります(増強される)
- でも,ガドリニウム造影剤が入らなくて白く映らないものもあります
- 周囲の小脳が腫れることが多いです(脳浮腫)
- CTでは石灰化がみられることがあります
- CTでは小脳より白っぽい灰色(高密度)に写ります
- 他の腫瘍との鑑別は,第4脳室腫瘍のところを読んでみてください
- 髄芽腫を疑ったらすぐに脊髄の造影MRIをします,転移があるかどうか探るためです
- 診断後にすぐに小児慢性疾患の手続きをすれば医療費が補助されます
典型的な小脳虫部(小脳の真ん中)の髄芽腫です。横の方,ルシュカ孔へ伸びていないので上衣腫と区別できます。ガドリニウムという造影剤で白く写っています。
この例は,小脳半球にできたものです。のう胞(水たまり)を形成しています。髄芽腫の大きな特徴は,造影剤を入れないCT(左側)で腫瘍が少し白く見えることです(灰白質より高密度といいます)。細胞密度が高いので高密度になります。この例はclassic medulloblastomaですが,MIB-1は45%に達するもので,急激な腫瘍発育を示します。
目標は生存率からQOLへ,いかに後遺症を少なくして生き延びるかという方向へと向かっています
分子生物学の知識や共同研究や新しい治験も大切ですが,それ以上に小児の悪性脳腫瘍を管理する臨床的能力が担当の医師にないと助かりませんし,大きな後遺症をかかえることになります
手術後の遺伝子診断に時間がかかって,治療開始が遅れると手遅れになることがあります
2024年時点で分子診断に基づいた新たな治療方法は開発されていません
治療はまず手術
- どこでも治療できる病気ではありません
- 手術で全摘出した方が生存のチャンスが増すと考えられていました
- でも最近は,後遺症を出してまで無理して全摘出しないという方向性にあります
- 手術で病理組織診断と分子診断をして,どんなタイプの髄芽腫か決めることが重要になりました
- 手術はむずかしいので経験のある脳外科医と施設を選んで下さい
- 手術摘出しなくても治るタイプの髄芽腫がありますが,その判断はものすごく難しいです
- 髄芽腫と画像診断されてもその施設に髄芽腫の経験が少ないなら,手術を受ける前に緊急で治療経験の多い施設へ移していただくことが大切です
- 手術後の治療の選択に迷った場合には,情報を集めてセカンドオピニオンを聞くことをしましょう,でも時間はありません
- 髄芽腫長期生存者での手術後遺症はとても多いです
- 手術では,髄芽腫細胞をばら撒いて,手術誘発播種を生じないように努めます
- 避けえないという側面もありますが,そんなことをしては元も子もない手術となります
手術後には病理診断をダラダラしないで,放射線治療か化学療法の準備と開始を少しでも急ぎます,そうしないと早期播種再発などに遭遇して助かりません
手術後の放射線治療
- 手術後の基本的な治療は放射線治療(脳脊髄照射 CSI)です
- 放射線は全部の脳と脊髄にかけなければなりませんが,年齢で脳脊髄照射の線量を調節します
- 脳脊髄照射に加えて腫瘍のある部位に局所照射をします
- かつては後頭窩照射54グレイが用いられましたが,小脳と脳幹部の被爆で認知機能低下が生じるので,腫瘍局所照射(腫瘍床 tumor bed, involved field)へと変わりました
- 年齢が低いと,放射線後遺症は強く出ます
- 問題は,治療後に何年もかかって悪化する学習障害あるいは認知障害(知能の低下)です
- 後遺症は手術と放射線で決まりますから,それをできる限り低侵襲に抑えるのが治療のコツです
- 脳脊髄照射は,高リスク群では36グレイくらい,標準リスク群では23.4グレイくらい,低リスク群は行わないという選択肢があります
- 8歳未満の年少児の標準リスク群では,認知機能の低下を避けるために低線量脳脊髄照射 18グレイ low-dose CSI が一般的になってきました
- しかし,低線量脳脊髄照射ではわずかながら生存割合が低下します
- 放射線治療も技術的に難しいのできちんと照射できる施設は多くはありません
- 脳と脊髄を一緒に照射する(1日で脳へも脊髄へも放射線治療をできる)ことが最低条件でしょう
- 限られた施設では,陽子線治療も用いることができるのですが,通常の放射線治療と比べての長期生存割合の差は証明されていません
- 陽子線治療を待っていて,その間に髄芽腫が播種してしまえば元も子もありません
手術後の化学療法
- 化学療法(制がん剤)も使って放射線治療の負担を下げようとするのが現在の考え方です
- でもしかし,化学療法だけでは治るのは限られた一部の髄芽腫だけです
- 完全に治すためには今でも放射線治療が最も効果があることを忘れてはいけません
- 化学療法は小児科の先生が行います
- 標準リスク群という治りやすい状態の髄芽腫での最も信頼のおける成績は,23.4グレイ脳脊髄照射と54グレイ腫瘍床照射,その後にシクロフォスファミド,シスプラチン,ビンクリスチンを使う化学療法を4コース加えるものです
- 2021年のSJMB03という大規模臨床試験でもこの化学療法が用いられています。
- とてもたくさんの量の制がん剤を使う大量化学療法で治るという証拠はありません
- 3歳未満の子供たちに放射線をかけるとてもつらい精神発達遅滞がおこりますから,化学療法だけでまず治療をすることにした方がいいです
- 特に,放射線治療が使えない年少のお子さん,播種してしまった髄芽腫,病理学的に治りにくい(退形成性髄芽腫など) と判断された時に大量化学療法が考慮されます
- 逆説的ですが,病理学的にとても治りやすいタイプ (MBEN, DPM, ウイングレス) で脳脊髄照射を省けると判断した時も大量化学療法を考えます
- MBENでは,german HIT trialという臨床試験が最も良い成績をあげていて,放射線治療を省く化学療法のみの治療方針です(後述の文献にあります)
- 播種再発の確率が高いグループ3髄芽腫では,放射線治療中にカルボプラチンを併用すると生存割合が改善します
- 化学療法でも,化学療法死や二次癌などの副作用はあるのでたくさんの量を使えばいいというものではありません
- メトトレキサート(メソトレキセート, MTX)の随腔内投与を行うと脳白質障害のために治療後の知能低下がひどくなりますから使用は勧められません
2019年からチオテパ(リサイオ)が保険診療で使用できます
- 特に,放射線治療を避けたい乳幼児や大量化学療法で治る見込みのあるタイプの髄芽腫に使用されます
- 適応は「小児悪性固形腫瘍における自家造血幹細胞移植の前治療」です
- メルファランとの併用で,1日一回 200mg/m2を使用するプロトコールのみの認可ですから,使用制限は厳しいです
水頭症(クリックすると詳しく読めます)
- 開頭手術で腫瘍を十分とれて第4脳室の詰まりがなおると治ります
- 水頭症にシャントをするとお腹の中に髄芽腫が転移しますから,シャントはしません
- 腫瘍摘出でも水頭症が治らない時には,内視鏡で第3脳室開窓術をします
治療後のこと(クリックすると詳しく読めます)
- 標準リスク群で年長児の5年生存割合は80%ほどに達するのですが,残念ながら3歳未満の子どもたちは50%くらいです
- 治療後に内分泌(ホルモン)障害が出ることが多いので小児内分泌の専門家に診てもらう必要があります
- 治療後の認知障害(知能の低下)は何年もかかってゆっくり進行します
髄芽腫の2021年 WHOの分類 全てグレード4
Medulloblastomas, molecularly defined
遺伝子診断がなされたもの
- Medulloblastoma, WNT activated
ウィングレス活性型,免疫組織染色で DKK1 (WNT)
- Medulloblastoma, SHH activated and TP53 wildtype
ソーニックヘッジホッグ活性型,TP53遺伝子野生型
- Medulloblastoma, SHH activated and TP53 mutant
ソーニックヘッジホッグ活性型,TP53遺伝子変異型
- Medulloblastoma, non-WNT/non-SHH
ウィングレスでもソーニックヘッジホッグでもないもの
Medulloblastoma histologicaly defined (grade IV)
組織診断のみによるもの
遺伝子診断ができないケースで髄芽腫と組織診断した時です
この基本的な4つの分子診断と,下の方に書いてある組織診断を組み合わせて,WHO診断名と病理学的なリスク診断とします
SHH activatedは,SHH活性型,SHH型,SHHタイプなどと日本語訳されていますが統一されていません。日常的には単に,ソーニックヘッジホッグということが多いです。
WNT activated
- ウィングレスの組織診断はクラシックタイプであり,低リスク腫瘍
- 治療がよく効いてほぼ全員が長期生存できます,一番治りやすい,でもグレード4です
SHH activated, TP53 mutated
- 大細胞/退形成性で高リスク,7歳−17歳に多い
- desmoplastic/nodular DNMB では低リスク
- ファンコニ貧血,ゴーリン症候群,リ・フラウメリ症候群に合併することがあります
SHH activated, TP53 wildtype
- クラシックでは,標準リスク
- 大細胞/退形成性では,臨床像との関連不明
- desmoplastic/nodular DNMB では,乳児では低リスク,成人にも見られる
- extensive nodularityは,乳児の低リスク腫瘍
non-WNT/non-SHH
- クラシックでは,標準リスク
- 大細胞/退形成性では,高リスク
- この中にグループ3が含まれています,group 3は髄芽腫の25%ほどを占めるもので乳幼児,男児に発生率が高いです。髄芽腫の中でも最も死亡率が高いものです。組織診断はclassicあるいはanaplasticで,高頻度にMYC増幅あるいはisodicentric 17qがあります。MRIでは小脳虫部発生で腫瘍境界がはっきりしないことがあり,ガドリニウムで強く増強されます。発症時から3割くらいの例で播種が認められます。
遺伝子診断のない髄芽腫:組織診断だけによるもの
Classic medulloblastoma CMB
Desmoplastic/nodular medulloblastoma DNMB
Medulloblastoma with extensive nodularity MBEN
Anaplastic/large cell medulloblastoma
遺伝子診断しなかった場合は,従来の組織診断だけで病名をつけておきます
2021年7月時点で,上記の 4 molecular subgroups とさらに予後の差異がある 12 subtypes があります
臨床所見を加えるともっと複雑なリスク分類になります
これによって治療方針が決められる方向にありますが,複雑で行き先不明?
- 遺伝子診断がなされないと上記の分類ができません
- 2021年7月時点で,上記の4 molecular subgroupsとさらに12 subtypesがあります
- 絶対的診断と信じられていますが,遺伝子診断の誤診というものも意外に多いです
- また遺伝子診断しても例外となるものは少なくありません
- 当てはまらないものを,medulloblastoma NOSと表現します
- MYC遺伝子増幅でもリスクが高まり,高リスク群になります
- 遺伝子診断にかかわらず,初回化学療法に反応が良いものは低リスクという事実があります
- 2021年時点で,この遺伝子診断でどの治療がベストというはっきりした選択肢はありません
- 従来の病理組織診断で,大細胞性/退形成性髄芽腫とされたものは全部,高リスクです,遺伝子診断しなくても同じ
標準リスク群の標準治療(Dr. パッカーの治療法)
CCNU/シクロフォスファミド,シスプラチン,ビンクリスチン
Packer RJ, et al.: Phase III study of craniospinal radiation therapy followed by adjuvant chemotherapy for newly diagnosed average-risk medulloblastoma. J Clin Oncol 24: 4202-4208, 2006
379人もの患者さんが無作為化比較大規模臨床試験(きちんとした臨床研究)で治療されてその分析結果がでました。対象は,播種のない髄芽腫で,かつ手術でほとんどとれていて,3歳から21歳までの標準リスク群に入る髄芽腫です。
基本になるのは,23.4グレイの脳脊髄照射と総線量55.8グレイの後頭窩照射です。その後に,CCNU,シスプラチン,ビンクリスチンを使う化学療法かシクロフォスファミド,シスプラチン,ビンクリスチンを使う化学療法のいずれかが加えられました。MTXの髄注は用いません。
手術後31日以内に放射線治療が開始され,放射線治療中は1週間に1度のビンクリスチン(1.5mg/m2)の投与がされています。多剤併用化学療法は脳脊髄照射の6週間後に開始されて,合計8コースが投与されました。
「結果」無増悪5年生存割合(再発などがなかった)は81%,全5年生存割合は86%でした。約5年の観察期間で7人の生存者に2次癌が発生しました。化学療法の違い(CCNUかシクロフォスファミド)では生存割合に差はありませんでした。最後に,外科手術での合併症による後遺症が多いことが触れられています。
2021年に報告された330名を対象とした大規模臨床試験 SJMB03 phaseIIIでは,同じ化学療法が4コース使用されています。
解説
- この報告は髄芽腫の無作為比較試験では最も大規模なものです
- とてもいい成績ですから,この報告をもって標準リスク群の髄芽腫では標準治療と呼べるものが確立されました
- 最も注意すべきことはこの成績が突出して良いことです
- 日本で同じことをして同じ成績が得られるとは思えません
- 手術後の放射線治療開始は31日以内と書かれていますが,現在ではもっと早期に開始するべきであるとされています
- この論文では後頭窩照射 55.8グレイが使用されていますが,この線量の後頭窩照射は知能低下を生じます
- 近年では腫瘍床に54グレイの原体照射 conformal tumor bed boostが一般的です
- CCNUは日本で手に入りませんが,シクロフォスファミド,シスプラチン,ビンクリスチンの併用化学療法は行うことができます
- ただし,放射線治療中のビンクリスチンの使用に関しては米国でも否定的な意見が多く,省くことができるかもしれません
- 低リスクの病理像を示す髄芽腫に8コースまでの化学療法が必要かということにも議論があります
- また,残存腫瘍1.5cm3というのは絶対的数値としての根拠があいまいで,ほとんんど摘出できたか,あるいは大きな残存腫瘍があるかという判断をした方が現実的です
- この論文の高い生存率は,髄芽腫の治療の体制が整った施設で,手術で髄芽腫が全摘できていて,術後の合併症を乗り切り,術後にも播種がなくて,ある期間までに脳脊髄照射が開始できた,3歳以上の髄芽腫で,化学療法が完遂できた症例の成績であるということです
- これらの条件を全て満たさなければ,同じ治療でこの高い成績は出ません
- この論文の条件として,手術で十分な摘出ができていない場合はこの治療法をそのまま適応することはできませんが,実際には残存腫瘍が大きくても同じ治療が応用できます
- しかし,どこかのタイミングで残存腫瘍を摘出する再手術 second-look surgery あるいは定位放射線治療による高線量boostが必要となることもあります
年少児でこの化学療法の投与量を多くしたらどうなるか?
Strother DR, et al.: Benefit from prolonged dose-intensive chemotherapy for infants with malignant brain tumors is restricted to patients with ependymoma: a report of the Pediatric Oncology Group randomized controlled trial 9233/34. Neuro Oncol 16: 457-65, 2014
3歳未満で,112人の髄芽腫が登録されたPOG 9233の結果です。標準的治療のおよそ1.8倍の化学療法剤が投与されましたが,この年齢層では化学療法剤の量を増やすだけでは,無増悪生存期間も全生存期間も改善しませんでした。
髄芽腫の手術について(患者さんの両親と脳外科の先生へ)
髄芽腫の手術は難しくて,この手術を的確にできる脳外科医は日本にほとんどいません
澤村自身にとっても髄芽腫の手術がとても難しいと考えていますし,思わぬつらい合併症に出会ったことはあります。髄芽腫の手術は簡単なものではありませんが,手術成績が長期生存割合に大きな影響を与えます。ですから,髄芽腫の手術経験のある脳外科医がいて,髄芽腫を治療できる設備のある施設で治療を開始したほうがいいです。そのような経験のある脳外科医がいない場合や施設では,患児をなるべく早く適切な施設に転送するようなシステムが必要かもしれません。手術だけしてから転院してはきちんとした治療ができないこともあります。
手術で最もしていけないことは,取れるはずの部分の腫瘍を取り残すことです。当たり前のことですが,取り残しが多いほど死亡率は高くなります。手術の合併症で頻度が高いのは,小脳失調と脳神経麻痺です。手術後遺症として,体幹失調,外転神経麻痺,顔面神経麻痺,眼球運動障害,嚥下障害をもっている子供たちをたくさん見ました。でも患者さん側からは,積極的な摘出が後遺症の危険と裏腹なことは理解してください。一時的に術後に出る症状として有名なのが小脳性無言症(後頭窩症候群)言葉が出ない無言)ですが,多くの場合は数日から数週間で改善していきます。しかし,この症状が出るとその後の知能発達と言語発達に影響が及ぶことがあります。
MRIで髄芽腫をみると一見して境界がはっきりしているように見えますが,実際に開けてみると小脳や脳幹部にベトベトくっついていて,脳組織からはがれてくれません。 でも,見える限りの腫瘍は摘出したほうが助かる確率は高くなりますし,逆に、無理な摘出は脳幹や脳神経の損傷を招きます。とても難しいので慣れていてもほとほと困った場面になってしまうことも多いです。脳神経外科医にとっても髄芽腫の手術は怖いものです。もちろん髄芽腫の中には放射線や化学療法がよく効くタイプもありますから,ひどい後遺症が出そうなら腫瘍を残したまま手術を終了します。
髄芽腫は,播種再発して死亡することが多い腫瘍です。手術の前に播種(転移)がなくても,播種再発して死亡する例はたくさんあります。このような例では,手術で腫瘍細胞をまき散らしてしまった可能性があると脳外科医は考えなければなりません。髄芽腫細胞は髄液の中で生き残れるので,ドロドロに柔らかい部分の髄芽腫を取っている時に,たくさんの腫瘍細胞を髄液の中にまき散らしている可能性は高いと思ってください。これを避けるためにはいろいろ工夫が必要です。例えば,超音波吸引器は洗浄水で細胞をまき散らすので使わないとかです。髄芽腫を治療する医師は,手術誘発播種ということばを知らなければなりませんし,そうしないように最大限の努力をします。
術直後の合併症として避けるべきなのは髄液の問題です。水頭症や髄液漏があると化学療法や放射線治療の開始の時期が遅れます。後頭部に皮下髄液貯留があると原因不明の発熱が長く続くことがあります。これは局所の感染ですが、CRPなどの炎症所見を示すデータが陰性になるために診断を誤ることが多いです。対策として、減圧開頭のような必要以上に大きな開頭をしないとか,craniectomyをしないとか,硬膜を焼かないとか,人工硬膜を使わないとか,術後出血を起こさないとか,中脳水道をしっかり開けるとか,僧帽筋の深部の縫合を緊密にするとか,手術の操作がしっかりしていればこのような問題は回避できることも多いのです。病理診断を急げば開頭術後の1週間以内に化学療法を開始することは可能です。しかし,全摘出の危険が高すぎる時など,髄液ドレナージをしなければ水頭症が改善できない場合もあります。
生存の質を保って生き残るための最も大切な第1歩は,化学療法でも放射線治療でもなく,安全な手術です
一方で,摘出手術をしないで治療するという選択肢はあります。なぜなら,世界標準治療は, まず手術,でも,症例分散のために,日本の脳外科医には髄芽腫の手術経験がほとんどない,かつ, 熟練している術者が存在しないかもしれないからです。
小脳性無言症 cerebellar mutism
主として小脳虫部発生の腫瘍の術後に出る症状として小脳性無言症(cerebellar mutism) と後頭下症候群 (posterior fossa syndrome)があります。意識はあって普通に反応するのに言葉が全く出ないという症状です。これは通常,数日から数週間で改善しまずが,小児でこの症状がでると将来の認知機能と言語の発達に遅れがでます。小脳深部白質あるいは虫部の大きな手術損傷がなければこの小脳性無言症は生じません。50%の患児では,術後16日以内に無言症から言語発出低下に移行します。この時点でも回復しない場合には認知機能障害が残ることが多いでしょう。
cerebellar fits, cerebellar seizures 小脳発作,小脳てんかん
小脳てんかん,小脳発作と呼ばれます。小脳扁桃ヘルニアあるいは脳幹部への強い圧迫がある状態で生じる症状です。症状は,頭痛から意識障害,てんかん類似発作です。強直性発作や軸剛性 axial rigidity と運動性自動症がみられます。大きな小脳損傷(腫瘍や出血)でもみられます。突然の転倒 drop attackや呼吸不全を伴うこともあります。大脳起源のてんかん発作と誤診されることがあるので注意します。
最近の手術の考え方
Thompson EM, et al.: Prognostic value of medulloblastoma extent of resection after accounting for molecular subgroup: a retrospective integrated clinical and molecular analysis. Lancet Oncol 2016 Mar 11
787例の髄芽腫の手術成績が解析されました。全摘出,亜全摘出(残存腫瘍<1.5ml),部分摘出で評価が行われました。全摘出と亜全摘出で比較した場合,全生存割合の違いはなかったというデータです。WNT, SHH, group 3で腫瘍を全摘出しても生存割合に対するbenefitはありませんでした。
「解説」無理して全摘しなくてもよくて,だいたい全部取れば良いということです。安全でより多くの腫瘍を摘出することは,今も標準治療 standard careなのですが,後遺症 neurological morbidityを出してまで無理して摘出してはいけないという結論です。小さな残存腫瘍が難しい場所にある場合は,second-look surgeryはしない。
治療後の再発は?
2021年時点で,髄芽腫全体での治療後の再発は30%ほど,ほとんどの再発は5年以内に生じるとされています。再治療では脳脊髄照射が使用できないので有効性は低く,その中での10%くらいの子供たちが5年を超えて生存します。
残念ながら,再発は播種再発が多いので治療方法はありません。PBSCTと大量化学療法を用いても腫瘍を消すことができず,脳脊髄照射も十分な線量を用いることはできません。テモゾロマイドやエトポシドなどの経口抗がん剤を服用して進行を少し遅らせるというような,緩和的な療法が用いられることが多いです。
生存率は?
正確には生存割合といいます。専門用語では,治療後5年の時点の無増悪生存割合 PFS とか全生存割合 OS とかいう用語を使います。でもこれらは,確実に治癒するという意味ではありません。どのような治療であれ,初期治療の後で再発すれば助かるチャンスは低く,治療の8年後に再発死亡する例もあるのですから。5年の時点で再発を抱えていては治癒への期待は薄くなります。とにかく最初の治療で治してしまえるかどうかが鍵です。
2005年の10月の論文で有名な米国のPaker RJという先生が, 標準リスクの髄芽腫患者さんでの5年生存率は80%くらいで,播種があったり3歳未満などのリスクが高い患者さんでも10人に7人くらいは生存できるとしています。でも,現実には3歳未満の子どもたちは50%以下と推定されます。欧州からの報告ではさらに10%くらい低くなります。この良い成績を日本に当てはめることはできません。更に,日本での髄芽腫の生存率はこれより10%くらい低いと見なければならないです。理由は治療の平均水準が低いから。
2021年時点でも全体を見れば,とても治りやすいタイプで8割くらい,治りにくいタイプでは3割くらいの子どもが長期生存できると考えられます。標準リスク群で5年無増悪生存割合は75-80%です。
ここから下は難しい
病気の進行具合の分類(チャンの病期分類)
もともとはChangという医師が40年くらい前に記載した分類 staging ですが改訂されて今も使われています。M0の方がM3 より治りやすいので,治療の方法も変わりますから重要です。M1というのは予後に関係ないということになっています (Shih DJ, 2014)。
- M0: 転移がない,髄液の中に細胞が散らばっていない,これが一番多いです
- M1: 髄液をとって顕微鏡で見る(髄液細胞診)と腫瘍細胞が見えることですが,細胞診での誤診(偽陽性)がよくありますし,予後にはあまり関係ありません
- M2: MRIで頭の中の脳室や脳槽に腫瘍の転移がある
- M3: MRIで脊髄に腫瘍の転移がある
M1を分類することは意義がありません。M2とM3は伴に治りにくい髄液播種ですから違いはありませんし,両方ともまとめてM3と考えたほうがいいです。M2とM3を併せてmacroscopic metastasis(肉眼的に見える転移)というと便利です。M4は内蔵や骨に転移するものをいいますが,現実にはほとんどないので意味がありません。
治療選択のためのリスク分類
リスク分類とは、治りやすい髄芽腫かどうかを見分けるためのものです。標準リスク群というのは治りやすいタイプといえます。治療方法を考える時の大分類となります。標準リスク群の治療法には標準治療(これをすれば良いという治療法)があると考えてよいのですが,高リスク群には定説がないと思います。精度の高いMRIが撮像できる現在ではM1は限りなく灰色です。3歳未満の小児には積極的な脳脊髄照射が使えないから高リスクになると捉える見方もあります。
- 低リスク群(low-risk tumor):WNT activated (classic),もしくは,SHH-activated TP-53 wild type (desmoplastic/nodular in infant/adult or extensive nodularity in infant)
- 標準リスク群 (standard-risk disease): まず,組織分子診断で低リスクと高リスク腫瘍を排除します。加えて,3歳以上の小児,髄腔内転移がない,手術で腫瘍がほとんど摘出されている(gross total or subtotal resection)の全てを満たすものです。
- 高リスク群 (high-risk disease, poor-prognosis group) : 3歳未満の乳幼児,髄腔内転移の存在 (M2, M3),術後の残存腫瘍の存在の一つを含むものと理解されます。残存腫瘍に関しては,かつては1.5cm3以上の残存腫瘍とさたましがこの数字は軽視される傾向にあります。2018年時点では,「かなりはっきりした大きな残存がある時のみ,あるいは残存腫瘍の有無は無視する」と解釈した方がいいでしょう,そうしないとやおら脳脊髄照射の線量が多くなり重篤な認知障害を生じる子どもの割合が高くなります。M1ステージでも同様です。組織診断で退形成性髄芽腫 large cell / anaplastic medulloblastoma といわれるものと,分子診断でMYC増幅のあるものは,高リスク群です。
標準リスクの髄芽腫
旧来の病理診断によるリスク分類
- medulloblastoma with extensive nodularity (MBEN)
- desmoplastic/nodular medulloblastoma (DMB)
- ordinary (classic) medulloblastoma (WNT-activated)
- ordinary (classic) medulloblastoma (WNTを除く)
- anaplastic medulloblastoma (AMB)
- large cell medulloblastoma (LCMB)
- (medulloblastoma with myogenic differentiation)
- (medulloblastoma with melanotic differentiation)
- (medulloblastoma with rhabdoid differentiation)
- (large cell/melanotic/myogenic mixed etc.)
髄芽腫の分子診断
2017年の分子分類,行き先さらに不明!
Schwalbe EC, et al.: Novel molecular subgroups for clinical classification and outcome prediction in childhood medulloblastoma: a cohort study. Lancet Oncol 2017
以下のようになり,この診断で治療の侵襲度を変えます。
MBWNT remained unchanged and each remaining consensus subgroup was split in two. MBSHH was split into age-dependent subgroups corresponding to infant (<4·3 years; MBSHH-Infant; n=65) and childhood patients (≥4·3 years; MBSHH-Child; n=38). MBGrp3 and MBGrp4 were each split into high-risk (MBGrp3-HR [n=65] and MBGrp4-HR [n=85]) and low-risk (MBGrp3-LR [n=50] and MBGrp4-LR[n=73]) subgroups.
Northcott PA, et al.: The whole-genome landscape of medulloblastoma subtypes. Nature 547, 2017
全ゲノム解析がなされました。特に今まで不明であったグループ3とグループ4のdriver geneが明らかにされました。
Driver mutations were confidently assigned to most patients belonging to Group 3 and Group 4 medulloblastoma subgroups. New molecular subtypes were differentially enriched for specific driver events, including hotspot in-frame insertions that target KBTBD4 and ‘enhancer hijacking’ events that activate PRDM6.
2016年までの分子診断の知見
Northcott PA, et al.: Medulloblastoma comprises four distinct molecular variants. J Clin Oncol, 2010
Remke M, et al.: Adult medulloblastoma comprises three major molecular variants. J Clin Oncol, 2011
Northcott PA, et al.: Subgroup-specific structural variation across 1,000 medulloblastoma genomes Nature, 2012
Shih DJ, et al.: Cytogenetic prognostication within medulloblastoma subgroups. J Clin Oncol, 2014
- ウィングレス WNTでは,播種があろうとどのような治療法であろうと95%くらいで治癒が期待できます (Shih DJ)
- ですから,チャンの病期分類はSHH, グループ3, グループ4だけで有用な分類となりました
- SHHでは,成人の髄芽腫の予後が良く小児では悪いです
- SHHでは,classic typeの方がanaplastic histologyより予後が良いです
- グループ3だけで,髄液播種の確率が突出して高くて,かつ長期生存割合も極めて低いです
- グループ3ではlarge-cell/anaplastic histologyの予後が有意に悪いです
- グループ3の長期生存割合は40%以下とみなされています(2016年時点)
- 逆に他のグループは播種転移の頻度が低く治る確率が高くなります
- 成人例ではこのグループ3が少ないのですが,成人ではWNTとグループ4の予後が悪いそうです
- グループ4の乳児は特に予後が悪いので,放射線治療が必須 critical のようです
- グループ4では,第10, 11, 17染色体の異常の有無から予後が良い例が選別できます
- 要するにグループ3以外は治りやすい腫瘍なのであろうということです
- これらのグループ分けをしてもなお,診断時の播種転移の有無 (M2/3)は予後に強い相関を有します
この分類に従えば,WNTとSHHとグループ4では化学療法を主とした治療にして,放射線治療は小脳の局所3次元原体照射で済むかもしれません。しかし,グループ3は従来の高リスク群に準じて,高線量局所照射と脳脊髄照射が欠かせず,血液幹細胞救援も視野に入れなければならないことになります。
手術をしないで化学療法から治療を開始するという選択肢
髄芽腫を画像診断してまず化学療法で腫瘍の縮小を計るという選択肢はあります。


3歳発症の髄芽腫です。M2/M3でしたから,生検術などせずに,脳室ドレナージをして,ICE化学療法で治療を開始しました。


化学療法を開始して21日目のMRIです,腫瘍はかなり小さくなっています。この後に,手術摘出(病理確定)や脳脊髄照射などをしました。この例はいずれにしても化学療法をする必用があったものです。
およその治療方針(ちょっとむずかしいかも)
髄芽腫では高リスク群と標準リスク群でという2つのグループに分けて治療法が選択されてきました。低リスクも加えて,3つのグループに分ける方法論はありますが,それに対する治療法はまだ確立されていません。高リスク群というは「治すのが難しいという意味」です。例えば2歳の髄芽腫で脊髄転移をしているのであれば治療がとても厳しいと理解して下さい。病理所見で悪性度が高い髄芽腫(退形成性髄芽腫,大細胞性髄芽腫,メラニン性髄芽腫)も高リスク群に入ると考えていいでしょう。
放射線治療
術後できる限り早い脳脊髄照射の開始を基本とします。2018年の論文でも手術後31日以内に開始することが条件として記載されています。標準リスク群に対して基本になるのは,23.4グレイの脳脊髄照射と総線量54グレイの腫瘍床照射です。3歳以上の患児に対しての照射は1日線量1.8Gy,週5回照射が標準的です。一方、高リスク群には脳脊髄照射24-36Gyが用いられますが,年令によってはこの線量は使えません。播種している髄芽腫では脳脊髄照射の線量はより大きくなります。腫瘍床の照射では3次元治療計画 3D conformal technique を用います。
発達過程にある乳幼児の中枢神経は放射線治療に対して著しく耐性が低く脆弱で,特に3才未満の小児に放射線治療を行えば重篤な中枢神経発達障害を招く確率が高いです。しかし,3才になってからも成人と同様の放射線治療ができるわけではなく,年齢に正の相関となるように放射線量を調節するために,低年齢児ほど照射線量を下げるため補助化学療法の役割は大きくなります。
spinal junction
脳脊髄照射を行う時にこの言葉がわからないと放射線治療がうまく行きません。全脳照射と全脊髄照射のつなぎ目(ギャップ)のことです。このつなぎ目には放射線量が十分に入らないので,その部分からの再発が多いと言えます。脳と脊髄は同日に照射しますから,そのつなぎ目を少しずつずらしながら毎日の脳脊髄照射を勧めて行きます。放射線が入らない領域を避けるためです。これは陽子線治療,IMRTでも同じことで,陽子線治療後の再発もspinal junctionに生じることが知られています。
脳脊髄照射の後遺症は一人一人でかなり違う
放射線治療は同じように行なっても,特に子どもの場合は,個人個人で有害事象(遅発性認知機能低下,学習障害,認知機能障害,高次脳機能障害,精神発達遅滞などと表現されます)がかなり違って出ます。例えば,7歳の子どもで脳脊髄照射を23.4グレイしても,普通に高校生になって社会人になる子どももいますし,小学校高学年くらいで特別な支援がないと学習できなくなる子どももいます。もちろん36グレイの脳脊髄照射ではほぼ確実に認知機能の低下は生じますから,何とかできればこの線量は避けたいです。ここをクリックしていただくと参考例が見えます。
この線量を選択するかどうかは,ソフィーの選択肢となります(ここをクリック)
化学療法
2006年にPacker先生は,3歳から21歳までの標準リスク群髄芽腫379人の無作為化比較大規模臨床試験の結果を報告しました。全摘あるいは亜全摘術後31日以内に放射線治療(23.4Gy全脳脊髄照射,55.8Gy後頭窩照射)が開始され,放射線治療中は毎週ビンクリスチン(1.5mg/m2)の投与がなされ,その後,ロムスチン,シスプラチン,ビンクリスチン併用化学療法あるいはシクロフォスファミド,シスプラチン,ビンクリスチンを使う化学療法のいずれかが,合計8コース加えられたものです。5年無増悪生存割合は81%,5年全生存割合は86%というすばらしい成績を残しました。化学療法の違い(ロムスチンかシクロフォスファミド)では生存割合に差はありません。この報告は,最大規模の無作為化比較臨床試験であり,かつ最も優れた成績を残した故に,今後の標準リスク群髄芽腫での標準治療とされるべきものになったと評価されます。
高リスク群においても低線量照射を用いる代表的成績は,23.4Gyの脳脊髄照射とロムスチン,シスプラチン,ビンクリスチンの併用化学療法用いるもので,約65%の5年生存率が得られたとの報告がああります。しかし,現在でも様々な化学療法プロトコールが模索されているのが現状です。2011年まで行われた研究でも,3歳以上の高リスク群(実際には播種がある)には,36.0- 39.6 Gyの脳脊髄照射と55.8 Gy conformal primary site boostが加えられ,さらに4サイクルの幹細胞救援を用いる高用量化学療法がなされています。一方で,高リスク群の中でも特に3歳未満の症例では,放射線治療を待機するために化学療法が先行して行われることが世界標準になりました。
播種がない3歳以下の低年齢層には造血幹細胞救援を併用する大量化学療法の有用性が期待されています。しかしこれも明らかな利点を証明するには至っていませんし,化学療法死を含めた強い副作用と生存期間延長の利害が厳密に比較検討されなければなりません。カルボプラチン,チオテパ,エトポシドを用いる地固め療法を21例の高リスク群に用いた研究結果では,無増悪3年生存率が49%であったと報告されました。この研究は髄液播種を伴う低年齢児を多数含んでおり照射を6歳まで待機する方針であるので期待が持てる成果とはいえますが、逆に大量化学療法といえども単独では半数以上に再燃が生じることを示しています。 日本でも一部の施設で行われていますがこれが有効かどうかの長期成績は正式には発表されていません。
澤村は1992年から2010年まで,年齢に応じた18-25Gyの脳脊髄照射とイホスファミド,シスプラチン,エトポシドを併用するICE化学療法を6コース用いる化学療法を併用するプロトコールを用いていました。2009年時点で,高リスク群も含めて治療後追跡期間中央値65ヶ月での5年生存率は70%程度でしたから欧米からの報告と大差はないものかもしれません。シスプラチンを中心とした併用化学療法は化学療法の中軸にあります。
2018年時点では,遺伝子診断の結果によって,化学療法のみで治療を行える髄芽腫を判別する方向性が主体です。しかし,まだ成功と言える報告がありません。逆に,「遺伝子確定診断を待っているうちに治療が手遅れ」,という子供たちの方が多いです。
制がん剤の効果はどのくらい?(小児科の先生と家族の方へ)
「髄芽腫は化学療法感受性が高い」という通説があります。この言葉の解釈はむずかしいです。髄芽腫の化学療法感受性(薬による治療が効くかどうか)は,実際には症例ごとに大きく違うのです。
第4脳室にとどまる髄芽腫(M0)も播種したの髄芽腫(M3)も,化学療法で完全に消えることがあります(CR; complete response)。しかし,精度の高い薄いMRI (1mmスライスの3D-CISSやガドリニウムMPR)で見直すと,ほとんどの場合で腫瘍は少し残っています。更にそれを手術で摘出すると残存腫瘍細胞が病理で証明されることがあります。ですから, 髄芽腫の化学療法によるCR率(著効割合)は論文で書かれている以上に意外と低いのです。消えた(CR)と思っても精度の高いMRIでは,PR(有効)例であるということは稀ではありません。
均一な小細胞 (small round cell)のみで構成される髄芽腫,結節性 (extensive nodularity)あるいは神経細胞への分化を含む髄芽腫 (neuronal differentiation, cerebellar neuroblastomaといわれたもの)とされる髄芽腫は一般的に化学療法感受性が高いと考えられてきました。2016年時点では,WNTやMBENなどのタイプが化学療法の有効性が高いと解っています。 逆に,化学療法にほとんど反応しない (NC:不変)髄芽腫もあります。このような例は同時に,放射線治療にも抵抗性の髄芽腫であると考えた方がいいでしょう。治療がとても難しい例です。メラニン性髄芽腫(medulloblastoma with melanotic differentiation)とか大細胞性/退形成性髄芽腫 (large cell/ anaplastic medulloblastoma)とかいわれる病理像をもった髄芽腫に多いのかもしれません。 これらは今でも,手術による完全摘出が命綱になるかもしれない例です。化学療法を行う時には,髄芽腫の病理組織像をしっかり見る必要があります。
髄芽腫が手術で全部取れてしまうと,その後に化学療法をしても,それが効いているのかどうかの判定ができませんから,化学療法抵抗性の髄芽腫かどうかわからないまま治療を続けることになります。もしMRIだけで髄芽腫が診断できて,あるがままの腫瘍に化学療法を行うことができれば,使った化学療法剤がその髄芽腫に効くかどうかがはっきり判定できます。澤村はそのようにして化学療法/放射線治療感受性を見てから髄芽腫の補助療法を決めていましたが,この考え方は一般的ではありません。髄芽腫はほとんどの施設で,最初に開頭腫瘍摘出術が行われますし,それが標準治療ですからお勧めはしません。手術もしないということは,逆に,先に書いたような病理も見ないで化学療法をするということですが,もう一つ大きな利点があります。手術が原因の髄液播種をなくせるのです。M0をM3にしないことは,全脳脊髄照射を避けるという将来の治療法にもつながるかもしれませんが,今はまだ科学的な根拠はありません。
脳脊髄照射の線量を下げる,局所照射の領域を絞るというのが放射線治療の負担の減量として大きな目標です。しかし一方で,神経毒性が少なくかつ有効な化学療法剤を選択するということもとても大切なことです。その意味ではメソトレキセートは避けられるべき薬剤です。

遺伝的素因によって発生する髄芽腫
遺伝子の異常がある先天性の疾患に髄芽腫が発生します。いずれの疾患に合併しても通常の髄芽腫よりは予後が悪いことが知られています。
ファンコニ貧血,ゴーリン症候群,リ・フラウメリ症候群は,ソーニックヘッジホック SHH pathwayの異常で髄芽腫を発症します。SHHタイプでは,遺伝カウンセリングが必要です。
- ターコット症候群 Turcot syndrome (related to germline mutations in APC)
- ルービンシュタイン-テイビ症候群 Rubinstein-Taybi syndrome (related to germline mutations in CREBBP)
- ゴーリン症候群 Gorlin syndrome (also known as basal cell nevus syndrome or nevoid basal cell carcinoma syndrome, associated with germline PTCH1 and SUFU mutations).
- リ・フラウメリ症候群 Li-Fraumeni syndrome (related to germline mutations in TP53)
- ファンコニ貧血 Fanconi anemia
文献情報
放射線領域の縮小と減量のトライアル
Michalski JM: Children’s Oncology Group Phase III Trial of Reduced-Dose and Reduced-Volume Radiotherapy With Chemotherapy for Newly Diagnosed Average-Risk Medulloblastoma. Clin Oncol 2021
標準リスク髄芽腫が対象で464例の大規模研究です。後頭窩照射 (posterior fossa)と腫瘍床照射 (involved field)が比較され,3-7歳では脳せき髄照射23.4Gyと18Gyが比較されました。結論は,5年無増悪生存割合は,後頭窩照射 80.5%とinvloved field 82.5%であり,腫瘍のあった場所だけにboostすればよいとのことです。後頭窩という広い領域は必要ありません。でも残念ながら,脳脊髄照射を18Gyに減量すると5年無増悪生存割合が低下してしまいます。
リスクに応じた治療法選択のための研究結果:大規模臨床研究
Outcomes by Clinical and Molecular Features in Children With Medulloblastoma Treated With Risk-Adapted Therapy: Results of an International Phase III Trial (SJMB03). J Clin Oncol 2021
SJMB03 臨床第3相試験の結果です。対象年齢は3-21歳,転移の有無と手術摘出度をもって標準リスクと高リスクに分けて治療が選択されました。4つのグループに分類され評価されました。330人が登録されました。5年無増悪生存割合 PFS は,標準リスクで83%,高リスクで59%でした。これは従来の報告と大きな差はありません。3つの低リスクグループが認められ,WNT, low-risk SHH, low-risk combined groups 3 and 4では,5年PFSが90%を超えました。従来どおり組織学的にはDNMBが低リスクです。逆に,2つの高度高リスクグループ,high-risk SHHとhigh-risk combined groups 3 and 4では,5年PFSは60%を下回りました。ERBB2変異の有無とPFSには関連がありませんでした。今後の臨床研究においては,これらの結果を踏まえてリスク分類による治療方針が立てられるとの結論です。
成人の髄芽腫は小児と異なる
Penas-Prado M: Proceedings of the Comprehensive Oncology Network Evaluating Rare CNS Tumors (NCI-CONNECT) Adult Medulloblastoma Workshop, 2020
分子マーカーが小児髄芽腫と成人では異なります。ですから小児髄芽腫が4つのタイプに分類され治療方針が決まり,予後が推定できるという仮説が成人では適応できません。例えば,monosomy 6は,小児では例外なくWNT髄芽腫にあるのですが,成人髄芽腫ではSHHとGroup 4に認められます。さらに,monosomy 6は成人では予後良好因子となりません。政治ではSHH-MBが70%の頻度を占め,SHH δタイプが多くを占めます。成人髄芽腫の30%ほどに,中枢神経内あるいは中枢神経外の播種再発があるのですが,それと分子マーカーの関連もわかっていません。
後頭窩症候群 posteriro fossa syndromeという用語は廃された
Schmahmann JD: Pediatric post-operative cerebellar mutism syndrome, cerebellar cognitive affective syndrome, and posterior fossa syndrome: historical review and proposed resolution to guide future study. Childs Nerv Syst. 2019
There is consensus among investigators in the international Posterior Fossa Society that the designation be retired. と書かれています。後頭窩手術後の合併症を総称する,後頭窩症候群は今後用いられなくなります。外科手術合併症を減じるリスク階層化のために,cerebellar motor syndrome, cerebellar vestibular syndrome, cerebellar cognitive affective syndrome including emotional dyscontrol, and mutismの理解が必要と説かれています。残念ながらこれらの症候を日本語に訳すことができず,日本の脳外科医の間の理解は遅れると思います。
陽子線のほうが知能予後が良い
Kahalley LS: Superior Intellectual Outcomes After Proton Radiotherapy Compared With Photon Radiotherapyfor Pediatric Medulloblastoma. J Clin Oncol. 2019
長く議論があった命題の答えかもしれません。2007年から2018年に治療された髄芽腫に,37人に陽子線が,42人に光子線(photon radiotherepy, 旧来の放射線治療)が用いられました。脳脊髄線量中央値は同じ23.4Gyで,平均年齢8.6歳,平均追跡期間は4.3年です。旧来の放射線治療では認知機能は低下しましたが,陽子線ではstable scoresであったそうです。そのまま受け取れば目立った知能低下はないと訳せます。この論文は今後の放射線治療に対して大きなインパクトをもつものです。
「解説」著者は,processing speedは陽子線でも低下したと強調しています。原発巣周囲の小脳には同じ高線量が入りますので,陽子線においても,小脳機能を介する認知機能としてのprocessing speedは低下すると理解されます。注意したいのは,治療対象となった年齢が髄芽腫にしては比較的高いこと,また対象が低リスク群であったという限定条件です。また脳脊髄照射は同じ線量が入っていますので,脳脊髄照射が23.4Gyという低線量条件において成立し得る治療成績です。
古い薬だけど経口エトポシドが有効な例がある
Perez-Somarriba M: Old drugs still work! Oral etoposide in a relapsed medulloblastoma. Childs Nerv Syst. 2019
分子標的治療薬の成果が見えない中,転移再発した8歳の女児に経口エトポシドが有効でQOLを保持して寛解維持できたという1例報告です。
再発治療後の生存
Jhonson DL: Survival Following Tumor Recurrence in Children With Medulloblastoma. Pediatr Hematol Oncol 2018
カナダからの550例の報告です。173例 (31%)が再発し再治療の結果,5年生存割合は12%でした。再発すると9割は助けることができません。
成人の髄芽腫も悪性度は同じ
Atalar B: Treatment outcome and prognostic factors for adult patients with medulloblastoma: The Rare Cancer Network (RCN) experience. Radiother Oncol. 2018
1976年から2014年までに欧米で集積された206人の髄芽腫患者さんの予後です。年齢中央値は29歳です。10年局所制御割合は46%,10年無増悪生存割合は38%,10年前生存割合は51%でした。エビデンスレベルは低い報告ですが,成人の髄芽腫が小児と同様に予後不良の高度悪性腫瘍だということはわかります。成人だからといって手を緩めてはいけない。
標準リスク non-WNT/non-SHH medulloblastoma の新たなサブグループ
Goschzik T, et al.: Prognostic effect of whole chromosomal aberration signatures in standard-risk, non-WNT/non-SHH medulloblastoma: a retrospective, molecular analysis of the HIT-SIOP PNET 4 trial. Lancet Oncol. 2018
2006年まで行われたHIT-SIOP PNET4の136例の解析です。グループ3とグループ4の髄芽腫のうち,特定の染色体異常があるもの(at least two of chromosome 7 gain, chromosome 8 loss, and chromosome 11 loss) は,予後が良い低リスク腫瘍に分類できるとの結論です。
3-5歳髄芽腫:リスク分類での治療選択で生存期間を延ばせなかった
Robinson G, et al.: Risk-adapted therapy for young children with medulloblastoma (SJYC07): therapeutic and molecular outcomes from a multicentre, phase 2 trial. Lancet Oncol 2018
3歳から5歳までの高リスクではない髄芽腫の治療です。手術から31日以内に放射線化学療法を開始しなければなりません。Lansky performance scoreは30%以上。低リスク,中間リスク,高リスクに分類されました。導入化学療法は同じで methotrexate, vincristine, cisplatin, cyclophosphamide です。高リスクの子供だけにvinblastineが加えられました。次いで地固め療法が行われます,それぞれ,
低リスクでは,cyclophosphamide (1500 mg/m2 on day 1), etoposide (100 mg/m2 on days 1 and 2), and carboplatin (area under the curve 5 mg/mL per min on day 2) for two 4-week cycles
中間リスクでは,focal radiation therapy (54 Gy with a clinical target volume of 5 mm over 6 weeks) to the tumour bed
高リスクでは,chemotherapy with targeted intravenous topotecan (area under the curve 120-160 ng-h/mL intravenously on days 1-5) and cyclophosphamide (600 mg/m2 intravenously on days 1-5).
全ての患児でcyclophosphamide, topotecan, erlotinib維持化学療法が追加されました。
低リスク群は成績が悪く登録は中断されました。 2017年までに81人が治療され,5年無増悪生存期間は31%でした。SSHのメチレーションタイプによっては予後が良いものがあったそうですが,信頼度は高くはありません。結論として,リスクに応じた治療選択は患児の無増悪生存期間を延長しませんでした。
幼い子のDNMBに対する治療のジレンマ
Cabdelbaki MS, et al; Desmoplastic Nodular Medulloblastoma in Young Children: A Management Dilemma. Neuro Oncol 2017
German (HIT) trialsの素晴らしい治療成績を受けて,2013年からACNS1221が3歳以下のDNMBに対しては放射線治療とMTXの髄注を行わないという試験を始めました。しかし,2年中間解析で再発が多くこの試験は中断されました。
転移している髄芽腫の治療成績
von Bueren AO, et al.: Treatment of Children and Adolescents With Metastatic Medulloblastoma and Prognostic Relevance of Clinical and Biologic Parameters. J Clin Oncol 2016
2001年から導入化学療法,多分割脳脊髄照射,維持化学療法を受けた,4歳以上の髄芽腫患者さん123人の治療成績です。5年無増悪生存割合は52%,全生存割合は74%でした。 DNMBでは89%と89% (n = 11)であったのに対して, large-cell/anaplasticでは20%と40%でした (n = 5) 。両者とも数は少ないのですがかなり大きな差です。遺伝子変異ではWNT winglessの予後が最も良い低リスクであることが確認されました。逆に,MYCC/ MYCN amplificationは高リスクと捉えられます。
今まで当然わかっていたのことなのですが,初回の化学療法の投与に反応した例で生存割合が高かったことを確認しています。初回投与で腫瘍陰影が顕著に縮小しなければその化学療法を変えたほうがいいという古い示唆でもあります。
3歳から8歳の幼い子に放射線治療を遅らせた場合には生存割合は下がる
Kann BH, et al.: Postoperative Radiotherapy Patterns of Care and Survival Implications for Medulloblastoma in Young Children. JAMA Oncol 2016
米国のデータベースの解析です。幼い子になるほど放射線治療の晩期障害が多いのは知られています。2004年から2012年まで,3歳の髄芽腫の子の37%が手術直後 (RT upfront) に放射線治療を受けず,時期を遅らせました (RT deferred)。8歳の子供では4%で放射線治療を遅らせました。予想以上に手術後の放射線治療の延期が生じる傾向にあるとのことです。しかし,5年全生存割合は,手術後放射線治療 upfrontで82%,遅延させた場合は63.4%でした。認知機能障害を避けるために放射線治療の時期を遅らせようとすれば,明らかに長期生存割合は低下するという結論です。
髄芽腫の陽子線治療
Yock TI et al. Long-term toxic effects of proton radiotherapy for paediatric medulloblastoma: a phase 2 single-arm study. Lancet Oncology Published online January 29, 2016
ボストンMGHからの報告で,2003年から2009年に59人の髄芽腫の治療成績です。14例の高リスク群の患児が含まれています。陽子線で脳脊髄18–36 Gy (GyRBE) (1·8 GyRBE per fraction)と局所照射が使用されました。全員が化学療法を受けており,脳脊髄線量中央値は23.4Gy,局所は54Gyでした。生存者平均追跡期間は7年です。45人中の4人(9%)で両側の聴力低下(grade 3-4)が生じ,3人で片側の聴力低下が生じました。5年での累積割合では16%でした。5年追跡期間でFIQが年平均1.5 point低下しました。内分泌機能は55%で低下していて,成長ホルモン欠損症が頻度として高かったとのことです。5年全生存割合は83%(95%CI 67-88)と推定されました。陽子線で,旧来の放射線治療と同等の生存割合を得られるとの結論です。
「CCLGのコメント」
中短期の観察期間において,陽子線による生存割合と副作用は旧来の放射線治療と同等である評価しています。理論的期待があるもののそれはまだ証明には至っていません。メディアで報道されたものは論文の著者によって書かれた結論に尾ひれがついているようで,一部の報道の陽子線に対する熱気に警告を発しています。
髄芽腫は再発すると治療抵抗性になる
Morrissy AS, et al.: Divergent clonal selection dominates medulloblastoma at recurrence. Nature 529, 351–357, 2016
Natureですが,臨床家にとっては当たり前といえば当たり前のことが証明されました。再発した髄芽腫では大部分で遺伝子変異が生じており,ある分子標的治療薬が初発時に効いても,再発時には無効となるということです。初発時の髄芽腫の中の治療抵抗性のクローンが生き残って再発する clonal selection のためであろうと解釈されています。
MRIで分子診断の予測ができるか
Patay Z, et al.: MR Imaging Characteristics of Wingless-Type-Subgroup Pediatric Medulloblastoma. AJNR Am J Neuroradiol 36: 2015
WNTウィングレス髄芽腫16例のMRI所見が検討されました。ルシュカ孔周辺から発生するlateralized tumorであったとのことです。大槽の方向ではなく,ルシュカ孔方向へと進展するものはWNTかもしれないということでしょうが,手術方針を変えるほどの所見ではありません。
SHH-MBグループにvismodegibが有効かもしれない
Robinson GW, et al.: Vismodegib Exerts Targeted Efficacy Against Recurrent Sonic Hedgehog-Subgroup Medulloblastoma: Results From Phase II Pediatric Brain Tumor Consortium Studies PBTC-025B and PBTC-032. J Clin Oncol 33:2646-2654, 2015
SHH pathwayを抑制するvismodegibの効果が試されました。成人例の再発SHH-MBで,31人中の3人で無増悪生存期間の延長が得られたそうですが,少数例報告で将来はわかりません。
MRSで分子分類が予想できる
Blüml S, et al.: Molecular subgroups of medulloblastoma identification using noninvasive magnetic resonance spectroscopy. Neuro Oncol 2015
MRSで髄芽腫の予後分類がある程度できるという報告です。Group 3/4 (17例)ではtaurineのレベルが高く,脂肪成分のレベルが低く,creatinineのレベルが高かったそうです。SHH (12例)では,chorineと脂肪が目立ち,creatinineのレベルが低く,taurineは同定できないとの結果です。Cr, Cho, myo-inositol, taurine, aspartate, lipid 13aの組み合わせでGroup 3/4とSHHの鑑別はかなりの制度でできるという結論です。
陽子線治療後の再発部位
Sethi RV, et al.: Patterns of failure after proton therapy in medulloblastoma; linear energy transfer distributions and relative biological effectiveness associations for relapses. Int J Radiat Oncol Biol Phys 88: 655-63, 2014
陽子線 protonの使用される頻度は高くなっているようですが,従来の放射線 photonによる治療成績との厳密な比較はまだなされていません。MGHで2002年から2011年に109人の髄芽腫が陽子線で治療されました。16例 (15%) で再発が生じました。テント上 8カ所,脊柱管内 11カ所,後頭窩 5カ所です。最も多い単独再発はspinal juncitonを含めた脊髄であり,従来のphotonによるCSIと変わりはありませんでした。
知能予後を考えるなら腫瘍局所照射も低侵襲にするべき
Moxon-Emre I et al.: Impact of Craniospinal Dose, Boost Volume, and Neurologic Complications on Intellectual Outcome in Patients With Medulloblastoma J Clin Oncol [Epub], 2014
113人の髄芽腫の子どもが追跡調査されました。脳脊髄照射が子どもたちの認知機能予後を悪化させるということはよく知られていることです。脳脊髄照射の標準線量standard doseは 30.6-39.4Gyであり,低線量reduced-doseは 18-23.4Gyとされていて,現在では特別な理由がなければ低線量脳脊髄照射がなされます。脳脊髄照射の後で腫瘍原発部位に追加照射がなされることが普通なのですが,その照射野の広さ boost volumeが広いと知能予後が悪くなるという結論です。特に,後頭窩照射が知能予後を悪化させるで再検討されるべきで,腫瘍床照射 tumor-bed boost を用いるべきであると勧告しています。また,水頭症に対する治療を要した患児での知能の悪化があったとのことです。
再発に対してはテモゾロマイドがある程度有効である
Cefalo G, et al: Temozolomide is an active agent in children with recurrent medulloblastoma/primitive neuroectodermal tumor: an Italian multi-institutional phase II trial. Neuro Oncol 16: 748-53, 2014
再発した髄芽腫あるいはPNETの42人の子どもたちがテモゾロマイドで治療を受けました。120-200m2を5日間使用する普通の使い方です。6人で腫瘍が消失しました(完全奏功),11人で部分奏功,10人で変化がなかったとのことです。PFS無増悪生存割合は6ヶ月で42%,1年で17%でした。これらの子どもたちは初期治療でかなりきつい化学療法を受けているにもかかわらずテモゾロマイドがある程度の有効性を示したと結論しています。
再発髄芽腫へのイリノテカンとテモゾロマイドの併用化学療法 TIMERI
Grill J, et al.: Phase II study of irinotecan in combination with temozolomide (TEMIRI) in children with recurrent or refractory medulloblastoma: a joint ITCC and SIOPE brain tumor study. Neuro Oncol 15:1236-1243, 2013
TIMERIとあえて名付けるほどのものでもなさそうです。3週間のうち5日間,テモゾロマイド 100-150mg/m2とイリノテカン 10mg/m2の投与がなされました。66人が治療され腫瘍縮小という意味でのobjective responseは33%の患者さんでみられ,奏功期間中央値は27週間(4ヶ月弱)で,生存期間中央値は16.7ヶ月でした。結論として,期待された奏功割合 tumor responseは得られませんでした。
低年齢の子どもに脳脊髄照射をせず後頭窩照射だけを使う
Ashley DM, et al.: Induction chemotherapy and conformal radiation therapy for very young children with nonmetastatic medulloblastoma: Children’s Oncology Group study P9934. J Clin Oncol. 30:3181-3186, 2012
8ヶ月から3歳まで転移のない74人の髄芽腫の子どもに,手術,導入化学療法,18-23.4Gyの後頭窩照射 (conformal radiation therapy),50.4-54Gyの腫瘍への照射,維持化学療法という治療がなされました。4年の時点での無増悪生存 EFSは50%,全生存割合 OSは69%でした。特に,desmoplastic /nodular typeでのEFSは58%と良好でした。7例では原発巣の増大,15例では転移が生じました。治療後に認知機能と運動機能の低下は認められなかったとのことです。結論として,この低年齢層で従来行なわれて来た化学療法単独の治療よりも,後頭窩照射を加えた方が無増悪生存割合が高いと述べています。
多分割照射の効果
Lannering B, et al.: Hyperfractionated versus conventional radiotherapy followed by chemotherapy in standard-risk medulloblastoma: results from the randomized multicenter HIT-SIOP PNET 4 trial. J Clin Oncol. 30: 3187-3193, 2012
無作為大規模研究です。4歳から21歳までの標準リスク群の340人が,多分割照射 HFRT hyperfractionated radiotherapyと通常照射 STRT standard radiotherapyで治療されました。化学療法は標準治療(シスプラチン,ロムスチン CCNU,ビンクリスチン)8コースです。5年無増悪生存割合はSTRT 77%, HFRT 78%で差がありません。全生存割合も87%と85%でした。治療成績に最も悪影響(strongest negative prognostic factor)を与えたのが手術後に残存腫瘍があることでした。手術後の放射線治療が7週間目以降になった患児の予後が一番悪かったとのことです。目的とされた聴力温存率は,HFRTとSTRTの間で差がないために,多分割照射の役割はないと結論されました。
「解説」繰り返し言われて来たことですが,この論文でもまた,手術で全摘出できていない場合,手術合併症で放射線治療開始時期が遅れる場合に生存割合は低くなると強調されています。
播種転移した髄芽腫の放射線治療中にカルボプラチンを使用する
Jakacki RI, et al.: Outcome of children with metastatic medulloblastoma treated with carboplatin during craniospinal radiotherapy: a Children’s Oncology Group Phase I/II study. J Clin Oncol 30: 2648-2653, 2012
161人の転移のある髄芽腫の患者さんが治療されました。全ての患者さんは,脳脊髄照射36Gyを受け,腫瘍のある部位に局所照射が追加されています。放射線治療中に従来のビンクリスチン週一回投与に加えて,CBDCA (30mg/m2/dose)が15-30回投与されました。放射線後は,CY/VCR化学療法かCDDP維持化学療法が6ヶ月間使用されました。前者での5年全生存割合が82%、後者では68%でした。退形成性髄芽腫の症例で成績が明らかに悪かったそうです。
「解説」また光顕病理の退形成を示す髄芽腫の予後が悪いことが確認されています。播種例の脳脊髄照射中のカルボプラチンの投与は期待が持てそうです。これは2012年の報告ですが,脳脊髄照射線量は相変わらず36グレイであることに注意して下さい。これ以下の線量では播種した髄芽腫を治すということはまだ難しいのです。でも,実際に全脳に36グレイも入ると治療後の認知機能低下は著しいものです。この線量は何とか避けたい,でもそれ以下で治るという保証はどこにもないということです。
FSTL5陽性の髄芽腫の再発率と死亡率が高い
Remke M, et al.: FSTL5 Is a Marker of Poor Prognosis in Non-WNT/ Non-SHH Medulloblastoma. J Clin Oncol. 2011
前に書いた4つのグループに分ける方法で,グループCとグループDでは治療経過が良い症例と悪い症例が混在していました。これをさらにFSTL5 (follistatin-like 5) で免疫染色すると陽性になった例での再発率と死亡率が有意に高かったとのことです。髄芽腫の治療予後を予測する prognosticationにこの染色方法はとても役に立つとの結論です。
「解説」もしそうだとすると,DKK1 (WNT), SFRP1 (SHH)とnon-WNT/non-SHH FSTL5 negative, non-WNT/non-SHH FSTL5 positiveに分ける方が治療方法を考えるのに便利で,non-WNT/non-SHH FSTL5 positiveの髄芽腫だけがどのような治療をしても最悪の経過をたどる群であるということになります。
MBENとDMBは化学療法でコントロールできる
von Bueren AO, et al.: Treatment of young children with localized medulloblastoma by chemotherapy alone: results of the prospective, multicenter trial HIT 2000 confirming the prognostic impact of histology. Neuro Oncol 13: 669-679, 2011
4歳未満の播種転移のない45人の子どもたちが治療を受けました。3サイクルの多剤併用化学療法と脳室内メソトレキセート注入です。腫瘍が消失しなかった場合のみに,再手術,放射線治療,大量化学療法などが用いられました。5年無増悪生存割合は57%,全生存割合は80%でした。desmoplastic/nodular MB (DMBとMBEN)では5年生存割合が100%であったとのことです。一方で,手術後残存腫瘍が無かった30人のうち29人で完全寛解が維持できたとのことです。
「解説」手術で全摘出で来ていれば化学療法のみで完全寛解が維持できる可能性が高いということです。またdesmoplastic/nodular MBの病理組織診断であればこの年齢層において化学療法のみで腫瘍のコントロールができるけれども,それ以外の組織型では無理なので局所放射線治療を応用することになったとのことです。
小さな子どもへの放射線前化学療法の効果
Rutkowski S, et al: Treatment of early childhood medulloblastoma by postoperative chemotherapy and deferred radiotherapy . Neuro Oncol 11: 201-210, 2009
1987年から1993年までHIT-SKK’87 trialで29人の髄芽腫の患者さんが治療されています。治療年齢中央値1.7歳であり,12.6年間追跡されています。使用された化学療法剤は,プロカルバジン,イフォスマミド,エトポシド,メソトレキセート,シスプラチン,シタラビンです。放射線治療は腫瘍が再燃した時あるいは3歳になってから使用されました。転移のなかった患児の10年無増悪生存割合は53%,全生存割合は59%でした。転移のあった3例ではそれぞれ0%です。病理組織でMBEN desmoplastic/extensive nodullar typeであった子どもは9割くらいが生存したということです。一方で,classic typeの髄芽腫では12例中の11例で化学療法中に腫瘍増悪が生じたそうです。もちろん放射線治療を受けた子どもの知能指数はそうでない子どもよりも低くなっていました。結論として,病理診断でdesmoplastic/extensive nodullar histologyがある小さな子どもでは化学療法によって脳脊髄照射を遅らせることができるであろうとしてます。
「解説」少数例ですが転移が生じている例では3歳未満といえども化学療法のみで治療を続けることが難しいようです。残念なのは定型的髄芽腫(classic histology)では化学療法で病勢の進行を抑制できなかったことです。12例中11例の増悪というのは高すぎるので,ここで用いられた多剤併用化学療法自体があまり良くない組み合せだったのかもしれません。3歳未満の随芽腫は病理細分類で、化学療法だけで治療できるかどうかが解るかもしれないということが書かれています。
髄芽腫治療の新薬
Rudin CM, et al.: Treatment of medulloblastoma with hedgehog pathway inhibitor GDC-0449. N Engl J Med 361: 1173-1178, 2009
hedgehog signaling pathwayというのが髄芽腫の増殖に深く関わることが知られていました。その経路を抑制して髄芽腫を治療する新しい薬,GDC-0449が再発して播種した髄芽腫を抱える26歳の男性に試されました。薬の投与後すみやかに腫瘍は小さくなって症状も良くなったそうです。
「解説」PTCH-1という遺伝子の変異がこの腫瘍にはあったので有効だったようです。同様の遺伝子変異がないと,またはhedgehog pathwayの活性化がないタイプでないとこの薬剤は効きません。また,この男性への薬の効果はtransient一時的だと書かれています。 ですから,この薬で髄芽腫が治るという結論にはもちろん達していません。
再発した髄芽腫への大量化学用法の効果
Gururangan S, et al.: Efficacy of high-dose chemotherapy or standard salvage therapy in patients with recurrent medulloblastoma, Neuro Oncol 10: 745-751, 2008
1995年から2005年までにデューク大学で再発髄芽腫30人の患者さんが治療されています。初期治療で化学療法のみで再発した7人と放射線化学療法を受け再発した12人は,導入化学療法の後で大量化学療法と自家幹細胞救援をうけました。一方,残りの11人は通常の化学療法のみを受けました。30人の内で生存したのは3人です。この3人は初期治療で放射線治療を受けていなかった患児で,再発治療の時に大量化学療法と十分な脳脊髄照射を受けることができていました。大量化学療法を受けても放射線治療が十分に併用できなかった12人では生存期間中央値35ヶ月で全員が死亡しています。
「解説」結局のところ初期治療で用いられるのと同等な放射線治療ができなければ,大量化学療法を使用しても再発した髄芽腫の長期生存は望めないということです。初期治療で放射線治療をしなければかなり高い確率で再発するのですし,再発した場合に十分な放射線治療ができても長期生存する望みは高くはないと読み取ることもできます。では髄芽腫が再発した時になにができるか?という疑問への答えはありません。今でも,再発した場合には,通常化学療法ををためして,もし有効であれば幹細胞救援を用いる大量化学療法での地固めと局所の追加放射線治療を加えるしか手だてはないのでしょう。
metronomic chemotherapyという考え方
Choi LM, et al.: Feasibility of metronomic maintenance chemotherapy following high-dose chemotherapy for malignant central nervous system tumors. Pediatr Blood Cancer 50: 970-975, 2008
Baruchel S, et al.: Safety and pharmacokinetics of temozolomide using a dose-escalation, metronomic schedule in recurrent paediatric brain tumors. Eur J Cancer 2006
メトロノーム維持化学療法という考え方があります。ほんの少しずつ休みなく繰り返し継続ていく化学療法のことです。代表的な薬剤にエトポシド,シクロフォスファミド,テモゾロマイドなどの経口連続投与があります。このメトロノーム化学療法は,難治性腫瘍の初期治療(部分寛解)に続くものであっても再発治療にあっても,あくまでも寛解維持療法であるという認識が大切です。寛解導入には,通常化学療法であったり大量化学療法であったりさまざまな方法があります。2009年初頭の現時点では,まだまだ確立された考え方とは全く言えませんから,安易に応用してはなりません。再発治療の後の寛解維持療法として応用を考えるべきです。初期治療後に消失(CR)している髄芽腫やジャーミノーマへの使用は行なうべきではありません。
転移した髄芽腫への多分割照射の効果
Gandola l , et al.: Hyperfractionated accelerated radiotherapy in Milan strategy for metastatic medulloblastoma. J Clin Oncol 2008
1998年から2007年まで33人の転移を伴う髄芽腫の患者さんが治療されています。手術後にメソトレキセート,エトポシド,サイクロフォスファミド,カルボプラチン化学療法を2ヶ月投与し,この化学療法には32人中の22人が奏効しています。一人が化学療法死しました。その後に,脳脊髄39グレイ(1回1.3グレイで1日2回の多分割)と後頭蓋窩へ総線量として60グレイ (1回1.5グレイで1日2回の多分割)の照射を受けました。化学療法後に腫瘍が消えた10歳未満の例で脳脊髄照射は31.2グレイに落とされています。初期化学療法で播種が消えなかった14人の患者さんには照射後に大量化学療法がなされています。5年無増悪生存割合は72%,5年全生存割合は73%でした。この放射線治療での厳しい副作用は認められなかったとのことです。
「解説」M1(n=9), M2(n=9), M3(n-17, M4(n=1) です。果たしてM1を転移 (metastasis)とするのか,M1例にこれほど厳しい治療が必要なのかまず疑問に思えます。M1を除いてしまえば5年無増悪生存割合は高いといえるのかどうか不明です。また,他分割照射といえども1日2.6グレイで脳脊髄照射が39グレイにおよぶ放射線治療での厳しい臨床的な合併症がなかったいうことを鵜呑みにできるかどうか不明です。イタリアのミラノからの報告と言えばそうらしいーー。でも,M3の播種例では失うものを覚悟しないと生命はたすからないというのも,まだ一方で事実ですから,この照射法を検討する価値もあるのでしょう。
化学療法を加えたことでの生存者の健康
Bull KS, et al.: Reduction of health status 7 years after addition of chemotherapy to craniopsinal irradiaiton for medulloblastoma: a follow-up study in PNET 3 trial survivors on behalf of the CCLG (formerly UKCCSG). J Clin Oncol 25: 4239-4245, 2007
年齢は6.6-24歳,147人の髄芽腫の生存者の調査報告です。健康状態は,脳脊髄照射単独よりも照射に化学療法を加えた生存者で劣っていたとしています。行動や生存の質も化学療法を加えた方が低く,運動や学習での支援が必要であったとのことです。
「解説」髄芽腫の治療の後遺症といえば,手術や放射線治療の影響が強調されますが,化学療法を加えることによっても生存者の健康状態は低下しているとしています。でも,化学療法を加えた方が生存割合はあがるので,かなりむずかしい判断となります。はっきり言えることは,はっきりした根拠の無い化学療法を加えてはならないということです。
手術後の無言症
Robertson PL , et al: Incidence and severity of postoperative cerebellar mutism syndrome in children with medulloblastoma: a prospective study by the Children’s Oncology Group. J Neurosurg 105: 444-451, 2006
小脳性無言症とは,小脳腫瘍の手術直後に一時的に言葉が出なくなることを言います。450人の髄芽腫の子供が手術を受けて,術後に小脳性無言症になったのは107人(24%)だったと報告されました。重い症状が43%,中等度が49%,軽症が8%でした。重症とは無言症と小脳失調症が顕著で,手術前に髄芽腫が脳幹部に浸潤していた例により多く発生したと強調されています。診断の1年後に,無言症がでた子どもの多くに,言語や認知機能障害や失調症 (nonmotor speech/language deficits, neurocognitive deficits, ataxia)が残っていました。
「解説」こんなに多いとはおどろきです。米国では髄芽腫はその手術になれている脳外科医がしますから,日本のように髄芽腫が一定の施設に集まらない所では,もっとこの合併症は多いと予想されます。やはり日本では,髄芽腫は手術しないで治す方法を探った方がいいのかもしれません。私は第4脳室腫瘍の術後にほとんど無言症をみません。原因はいろいろ推定されてはいますが、ほとんどの場合は、手術で小脳虫部というところを切開しすぎ、小脳深部損傷を生じることに起因します。
大量化学療法の脳脊髄照射への併用
Cajjar A , et al: Risk-adapted craniospinal radiotherapy followed by high-dose chemotherapy and stem-cell rescue in children with newly diagnosed medulloblastoma (St Jude Medulloblastoma-96): long-term results from a prospective, multicentre trial. Lancet Oncol 7:813-820, 2006
幹細胞救援 PBSCT を用いる大量化学療法の成績です。放射線治療の量をリスクに応じて変えています。標準リスク群では化学療法の前に23.4グレイの脳脊髄照射が,高リスク群では36-39.6グレイの脳脊髄照射がされています。腫瘍局所線量はいずれも55.8グレイです。大量化学療法の薬剤は,シスプラチン,ビンクリスチン,サイクロフォスファミドです。134人の患児の内の119人(89%)で治療をきちんと終えることができました。標準リスク群での5年全生存割合は85%で高リスク群では70%でした。組織像をみると大細胞性髄芽腫large-cell medulloblatomaでは57%の5年生存割合だったとのことです。
「解説」St Jude (セントジュー)病院のプロトコールとして知られる治療法の報告です。とてもいい成績です。でも,大量化学療法の前にすでに標準リスク群では23.4グレイの脳脊髄照射が高リスク群では36-39.6グレイの脳脊髄照射が併用されていることに注目です。従来の放射線治療に大量化学療法をかぶせればいい成績なのですが,これは大量化学療法単独だけの有効性を確認したものではありません。また標準リスク群では,上に書いてあるPacker先生の報告と同じくらいなので,副作用(有害事象)が強い大量化学療法は標準リスク群には使うべきでないと判断されます。一方,高リスク群には試してもいい治療法ですが、脳脊髄照射36グレイは減量できません。この治療は米国の巨大な小児病院で多くの専門スタッフのもとでのみ可能な治療法ですし、大量化学療法は化学療法死の他にもたくさんの有害事象があり得る治療だということも忘れてはいけないでしょう。
手術する前にしっかり化学療法を行うこと
Grill J et al. Preoperative chemotherapy in children with high-risk medulloblastomas: a feasibillity study. J Neurosurg (Pediatrics 4) 103: 312-318, 2005
フランスのパリの小児病院からの報告です。高リスク群(Chang M>1, or T3b/T4)の21人の子供に水頭症の治療(脳室開窓術13例とシャント術6例)と生検病理診断を行った後に,通常化学療法(8例)あるいは大量化学療法(11例)をしてから腫瘍摘出術が行われました。1例で生検術のとき腫瘍内出血があります。手術前に播種した2例が亡くなっています。大量化学療法関連死は1例です。脳脊髄照射は5歳以上に,それ以下の子供は局所照射を受けました。
2コースの化学療法の後での腫瘍への奏功率は71%,転移巣への奏功率は59%です。化学療法後に摘出された残存腫瘍の病理は,7例で髄芽腫組織,3例で腫瘍がない脳組織のみ,9例で両者が混じったものでした。3年無増悪生存率は期待に反して低く37%でした。
「Dr. Packerの解説」手術前化学療法の意義があるとすれば,腫瘍の大きさを縮小して手術を安全に(特に大きな腫瘍で生じる後頭窩無言症の頻度を下げる)かつ完全摘出を確実に可能にすること,そして生命予後を改善するにあるのですが,この報告で術後の後頭窩症候群(何らかの小脳脳幹損傷)が19例中の9例に生じているのに失望?しています。
また,あらかじめ手術をして病理組織を確かめるのがとても重要なのにそれの反対を行く方法なので納得できないと述べています。理由は,2歳未満の子供の未分化腫瘍の4分の1がAT/RT(とても治らないような悪性腫瘍の一つです)であること,最近の米国の共同研究では治療を始める前に病理所見の中央診断をしていること,分子マーカー(ERBB2 protein, MYCC and TRKC messenger RNA)が予後因子(生物学的悪性度を予想する)となるのにそれが解らなくなるために治療のintensity(強さ)が決められなくなるとしています。
「澤村の印象」この報告は積極的摘出手術のリスクを下げようとした観点からはとても興味深いものです。そして,高いリスクの髄芽腫にまず大量の化学療法のみがされたということに注目です。摘出術前放射線治療は使われませんでした。
前のところに書いたように髄芽腫の手術は簡単なものではないので,腫瘍を小さくしておいてから,開頭手術で全部取れればそれに越したことはないのです。ちょと観点を変えて,リスクの低いと思われる髄芽腫に,まず軽い化学療法と局所放射線治療で小さくしてから手術をするという方法もあるのではないでしょうか。もちろん効果を確実に予測する方法はありませんし,ここでは書ききれないくらい様々な問題を含んではいます。
標準リスク群への25Gy全脳脊髄照射の成績
Oyharcabal-Bourden V et al.: Standard-risk medulloblastoma treated by adjuvant chemotherapy followed by reduced-dose craniospinal radiation therapy. J Clin Oncol 23: 4726-4734, 2005
フランスの小児脳腫瘍グループらかの発表です。3歳から18歳の子供で,手術でほとんど腫瘍が取れて,かつ転移もない(標準リスク群)136症例の治療成績報告です。標準的な脳脊髄照射は35Gyが使われますが,それだと認知障害の発生率が高いので,25Gyまで脳脊髄照射を落としているのが最大の特徴です。術後90日以内(ちょっと遅い!)に放射線治療を開始して,腫瘍のあった部分には55Gyを照射しています。化学療法は 8 drugs in one day という良く知られた多剤併用療法を2コースとカルボプラチン/エトポシドを2コース使っています。末梢血幹細胞救援を使う大量化学療法ではありません。
全体での5年無増悪生存率は65%で,治療がうまくいかなかった例では放射線治療や術後の評価がきちんとされていなかった例が多いということです。また,計画に沿ってきちんと治療がされた 症例での5年無増悪生存率は72%であると報告されています。生存した31%の子供に成長ホルモンの補充が行なわれて,25%の子供に特殊な就学指導が必要であったとのことです。
「解説」標準リスク群 では多剤併用化学療法を組み合わせることで,25Gyの 脳脊髄照射でも70%程の再発のない5年生存率が得られるということを証明しています。放射線治療は手術後にあまり待たないで行なうことと,放射線治療計画がしっかりしているという条件が揃っていてこの成績が出ていることに注目です。放射線照射の時期を遅らせればこの治療成績は期待できないかもしれないのです。おそらく10歳以下の子供たちでは,この脳脊髄線量25Gyでもかなり高率に下垂体機能障害と認知障害が出ますが,その程度と割合は従来の35Gyに比べれば軽いといえます。同量の脳脊髄照射を用いるPackerの
3歳未満の髄芽腫への化学療法
Rutkowski S, et al.: Treatment of early childhood medulloblastoma by postoperative chemotherapy alone. N Engl J Med. 2005 Mar 10;352: 978-86, 2005
New England Journal of Medicineというとても権威の高い雑誌に、Dr. Rutkowski(ワルツブルグ大学小児腫瘍科)が髄芽腫の治療の論文を発表しました。髄芽腫をもつ3歳未満の子供たちに放射線治療をしないで化学療法だけで治療しようという計画の成績です。放射線治療は腫瘍が消えなかった場合と再発した時に使われました。
1992年から1997年に治療された43人の3歳未満の子供たちの治療成績です。手術の後で3コースのシクロホスファミド、ビンクリスチン、メトトレキサート(メソトレキセート)、カルボプラチン、エトポシドの静脈内投与と脳室からのメトトレキサートの投与を行っています。1コースに2ヶ月かかりますから短くても6ヶ月の化学療法ですが、この研究で用いられたのは造血幹細胞救援を併用する大量化学療法ではありません。
- 完全摘出を受けた17人 5年生存割合 93% (無増悪生存割合 82%)
- 残存腫瘍があった14人 5年生存割合 56% (無増悪生存割合 50%)
- 転移(播種)があった12人 5年生存割合 38% (無増悪生存割合 33%)
転移のなかった31人では5年生存割合 77% (無増悪生存割合 68%)。初期化学療法の終了時点で腫瘍が消えなかった14人のうち10人が死亡して、残りの4人は更に放射線化学療法を受けて生存。初期化学療法で腫瘍が消えていた(手術全摘を含む)29人の9人に再発が生じています。16人は増悪・再発の時に放射線化学療法を受けて、その内で8人が再発治療に成功したということです。23人の子供の内で無症状ながら白質脳症がみられたのは19人(83%)です。治療後の知能指数は放射線治療を受けた過去の臨床試験の患者さんより高く保たれたとされています。
「解説」3歳未満という治療がとても困難な子供たちを治療した成績ですから、結論としてこの化学療法の成績はとても良いものです。
この報告の結果でも,手術後に残存腫瘍があれば半数の子供が死亡して、播種があれば3分の2が死亡します。ここで際立つのは手術で腫瘍が完全(complete)に摘出できた場合の無増悪5年生存割合が80%にもなることです。これは3歳以上の髄芽腫の子供たちでもなかなか到達できる成績ではありません。以前から解っていた事なのですが、あらためて手術の結果が化学療法の成績にも極めて大きな影響を及ぼすといえるでしょう。上衣腫でも同じ事がいえるのですが、MRIで見える腫瘍はなんとかかんとか全て摘出した方がいいと実感します。
初期治療で腫瘍が消えなかったときにはとても高い死亡率になりますから、放射線治療を追加しなければなりません。また消えていても再発して放射線化学療法を追加した時の死亡率は50%を超えるものと思われます。それに論文の成績はとてもすばらしいのですが、同じ計画で追試が行われなければ本当の価値は判りませんし、同じプロトコールで追試された場合でも成績が悪くなる事はよくあることなのですから、眉毛につばをつけて慎重に評価しなければなりません。この論文でも化学療法のみで腫瘍が消えた場合に放射線治療を行わないという方針は3歳以上の子供ではなされていませんし,3歳になっても放射線治療をしないという考え方は一般的ではありません。
この治療法ではメトトレキサートの投与をしていますが、原則として放射線治療を加えないという仮定のもとでの計画である事に特に注意しなければなりません。全脳脊髄照射をしない「計画」なので播種をコントロールするためにメトトレキサートの髄腔内投与を行ったのでしょう。知能検査の結果が脳室内のメトトレキサート投与(放射線治療なし)で,放射線治療を受けた子供たちよりは良いとのデータです。これと同じ化学療法をして3歳を超えてから放射線を追加するプロトコールを作れば白質脳症は必ず増えます。実際にこの論文の中でも,23人中15人の子供に中等度から高度の白質脳症が画像上で見られて,再治療時に脳脊髄照射を受けた6人の子供にグレード2と3の白質脳症が発生したと書かれています。
この論文の成績をみる限り用いられた化学療法の成績はとても期待できるものです。手術の完全摘出の重要性が際立ちます。また、3歳未満ですでに転移(播種)がある症例では死亡率は極めて高いので、さらに強い化学療法、自家造血幹細胞救援を併用する大量化学療法が試みられるべきである事を示唆しています。
振り返って思い出さなければならない論文に,Riva D et al: Intrathecal methotrexate affects cognitive function in children with medulloblastoma. Neurology 59: 2002 があります。この論文では メトトレキサートの髄腔内投与を受けた髄芽腫の子供の認知障害(知能の発達遅延)が他の化学療法を受けた子供たちより高度であり,白質脳症と認知障害には明らかにメトトレキサートの投与と関連しているので髄腔内投与は再考しなければならないとしています。放射線量を下げてもメトトレキサートを使用すれば元も子もなくなる可能性があります。
播種した髄芽腫への照射前化学療法
Taylor RE, et al: Outcome for patients with metastatic (M2-3) medulloblastoma treated with SIOP/UKCCSG PNET-3 chemotherapy. Eur J Cancer. 2005 Mar;41(5):727-34
播種(M2-3)した髄芽腫68例の治療成績です。1992年から2000年まで,年齢中央値7.8歳の子供たちにビンクリスチン,エトポシド,カルボプラチン,シクロフォスファミドを使った化学療法を行って,その後で放射線治療をした成績の発表です。化学療法の後で,35Gy/21分割の脳脊髄照射と20Gy/12分割の後頭窩照射,転移巣への追加照射が用いられています。治療後の観察期間中央値は7.2年で,全5年生存割合は44%(無増悪5年生存割合は35%)との結果です。この化学療法の奏功割合(腫瘍が縮小したこと)は73%程にもなるのですが,過去の報告と比較して生存率を改善するという明らかな利点はなかったと結論されました。
「解説」この論文の結論のように,現在では照射前化学療法は否定される方向にあります。できれば放射線治療を前にという方法が強いと考えます。
なぜ術後残存腫瘍が1.5 cm3以上と以下で治療方針が変わるのか
Zeltzer PM, et al.: Metastasis stage, adjuvant treatment, and residual tumor are prognostic factors for medulloblastoma in children: conclusions from the Children’s Cancer Group 921 randomized phase III study. J Clin Oncol 17: 832-845, 1999
“eight-drugs-in-one-day” (8-in-1) 化学療法を放射線治療(54 Gy tumor/36 Gy neuraxis) の前後に行なうという試みがなされ,結論としてこの化学療法の有効性は否定されました。この研究の中で,3歳以上でM0の生存曲線を解析すると,術後残存腫瘍が1.5cm3以上あった群では5年生存割合が54%で,それ以下の群では78%であったとのことでした。この後,1.5cm3 (ml, cc)という値が一人歩きを続けました。
髄芽腫の疾患概念(専門家向け)
- 髄芽腫は小児の中枢神経に発生する胎児性腫瘍の中では最も頻度が高いもの
- 小脳とくに下髄帆の幹細胞(外顆粒層細胞や上衣下基質細胞)より発生し,強い浸潤・転移性格を有する腫瘍
- 日本脳腫瘍統計における発生頻度は,全原発性脳腫瘍の1%ほど,小児に限ってみれば小児脳腫瘍の12%ほど
- 発症年齢は14歳以下が90%と多く,性別では男児に多い
- 発生部位は,小児例の7割が小脳虫部に発生しするが,成人になるにつれ小脳半球に発生することが多くなる
- 原発巣の小脳から髄腔内への播種転移を生じる可能性が高く,髄液播種がある例と小脳に限局する例では治療法の選択と生命予後が大きく異なる
- 発生の原因に関しては,ウィルスなどの発生要因説があるが定説はない,母親の喫煙,ダイエットなど腫瘍発生に関する環境因子の影響はないとされている
- 極めてまれに,先天的な遺伝子異常,放射線被曝,免疫不全などが発症と関連性がある
- 遺伝性の疾患では,Li-Fraumeni症候群,Nevoid basal cell carcinoma症候群(Gorlin’s症候群),Turcot’s症候群A(ウィングレス髄芽腫),Rubenstein-Taybi症候群などが挙げられる
髄芽腫のいろいろ
medulloblastoma with extensive nodullarity
2歳の子どもにできたmedulloblastoma with extensive nodullarityのMRI CISS image矢状断層。多数の結節に分かれるこのタイプの髄芽腫は3歳未満の小児に発生し,化学療法によく反応します(右は1コースのICE化学療法後の顕著な縮小を示します)。従って,classical medulloblastomaよりも予後が良いといえます。リスクを侵して全摘出する必要はなく,また幼児発生であることも考慮すれば放射線治療の intensityも高く設定する必要はないのかもしれません。同じ3歳未満のhigh-risk groupの髄芽腫といえども,2歳児のanaplastic medulloblastomaとは治療反応性に天地の開きがあります。
desmoplastic/nodular medulloblastoma
このタイプも治りやすい髄芽腫に分類されています。左がGFAP,右がsynaptophysinです。グリア系への分化を示すGFAPに染まる部分で細胞の増殖力が高くMIB-1の染色率も高いです。島状(結節状)になっていてsynaptophysinで染まる神経細胞への分化を示す部分では,細胞増殖割合は低いです。髄芽腫では神経細胞への分化が観察される分化型のもので治療反応性が良いと考えられます。
medulloblastoma with melanotic differentiation
腫瘍細胞の細胞体にはメラニン顆粒が充満している。このタイプの髄芽腫は治療抵抗性であり手術全摘できなければ予後は不良です。術中病理診断でこれが判明すればradical resectionへ向うほうがよいのでしょう。なお,この例では手術顕微鏡下の肉眼観察でも腫瘍表面にメラニン沈着が明らかでした。脳組織への腫瘍浸潤が顕著であり脳幹部症状を出さなければ腫瘍全摘出ができないものでした。外転神経と顔面神経核を損傷することが解っていながら,ご両親と相談して全摘出に踏み切りました。
anaplastic medulloblastoma LC/A MB 退形成性髄芽腫
光顕病理のレベルで髄芽腫のおよそ4分の1にみられ悪性型と分類される退形成性(大細胞性)髄芽腫 (anaplastic / large cell medulloblastoma) は古くから悪性度が高いものとして知られてきました。この群ではErbB2蛋白を発現し,ErbB2遺伝子が高発現する髄芽腫は転移しやすく核分裂像が増加するとい報告があります。Gajjarらによれば標準リスク群かつErbB2陰性の26例での5年生存率が100%であり,一方ErbB2陽性の13例での5年生存率が54%(P=0.0001)であったということです。この事実が検証されれば標準リスク群の治療強度はErbB2の発現の有無により大きく変化するのでしょう。
左は1歳児に発生した一部に神経芽細胞腫様の分化 row of the tumor cells (or neuronal differentiation) を伴う髄芽腫 medulloblastoma with extensive nodularity(小脳神経芽細胞腫 cerebellar neuroblastomaともいわれたもの)。右は7歳児の退形成(核の異形成)が顕著な退形成性髄芽腫 anaplastic medulloblastomaです。前者の治癒率は高く,後者の病理像の治癒率は極めて低いものです。
退形成性髄芽腫
標準リスク群においてはanaplastyが生存率に大きな影響を与えないという報告もありましたがそれは誤りでした。この病理像を有する髄芽腫の予後は悪いです。


7歳児の小脳半球にある標準リスクの髄芽腫です。画像を一見すればこの髄芽腫は治るであろうと予測します。


手術で完全摘出し,退形成性髄芽腫の病理診断で,脳脊髄照射と局所照射54グレイ,シスプラチンベースの化学療法を6コース加えましたが,半年後に激しい播種再発を生じました。
症候と診断
小脳に発生し脳幹を圧迫するため,局所神経症候としては体幹失調としての歩行時のふらつきや眼球運動障害が認められます。また,第4脳室を閉塞して水頭症を生ずるため,頭痛や嘔吐などの頭蓋内圧亢進症状にて発症します。
単純CTでは,腫瘍は比較的境界明瞭で石灰化も高頻度に認められます。充実性腫瘍であることが多いのですが,のう胞あるいは壊死形成も見られます。細胞密度が高い腫瘍であるのでCT等吸収域もしくは高吸収域として描出され,造影剤では均一に強く増強されます。MRIでは,T1強調画像で低信号域として描出され,T2強調画像で等信号から高信号を呈すします。ガドリニウム増強効果は症例により様々であり,強い均一な増強効果を示す例から,ほとんど増強されない症例まであります。髄液播種の頻度が高いので,全脳脊髄にわたるMRI検査が必須です。また,MRIで髄腔転移が認められなくとも髄液細胞診で陽性となることがあるので,もしできれば腰椎穿刺あるいは脳室内髄液によって細胞診を行います。
放射線治療の歴史
現在においても,髄芽腫を治癒に導く確実性が最も高い治療法は脳脊髄照射です。かつては,化学療法を併用せず脳脊髄照射36Gyと後頭蓋窩照射54Gyのみが標準治療線量とされ,この放射線単独治療での標準リスク群の5年無増悪生存割合は60-70%くらいでした。
1980年代にCOGとCCGで行われた脳脊髄照射の無作為比較試験の最終結果が,2000年にJ Clin Oncolに発表されました (Thomas et al. 2000)。標準リスク群126人を36Gyと23.4Gyの脳脊髄照射がrondamizeした結果、23.4Gyの低線量脳脊髄照射では早期再発と播種のリスクが高く、かつ5年無増悪生存割合 (52%) と全生存割合も低かったのです。 放射線治療単独23.4Gyでは半数の標準リスク群随芽腫でさえ制御できないことが解り、これ以降は化学療法の併用が必須であるという方向へと向かいました。
2009年時点で標準リスク群に対して基本になるのは,化学療法を併用した23.4グレイの脳脊髄照射と総線量55.8Gyの後頭窩照射です。3歳以上の患児に対しての照射は1日線量1.8Gy,週5回照射が標準的です。一方、高リスク群にはなお脳脊髄照射35-36Gyが用いられましたが、この線量は小児の認知機能の発達にかなりの遅滞を生じました。
脳脊髄照射では、脳照射と脊髄照射を同日に行うこと、つなぎ目の部位への線量の調節,前頭蓋底の篩板周囲への照射,脊椎椎間孔や後頭窩局所照射での領域設定など,治療計画に細心の注意と3次元治療計画技術が発達してもいます。
更に照射装置の発達,治療計画の高度化,後頭窩照射の廃止など常に変化しています。
放射線治療のによる遅発性認知機能障害
1990年Hoppe-Hirschらは髄芽腫120例を追跡し、治療5年後には42%の患児でIQは80を下回り,治療10年後には85%の患児でIQは80を下回ると報告しました。2001年のRisらの報告によれば,23.4Gyの低線量脳脊髄照射によっても知能低下は明らかではあるが,旧来の放射線治療と比較すれば知的機能の温存率は改善の傾向があったということです。しかし,患児のIQは1年あたり4.3低下していき,7歳以下で低下率は著しく,3年経過観察した15症例の平均FSIQは75.7であり更に低下の傾向をたどるということでした。さらに近年,5歳以下の標準リスク群に脳脊髄18Gyという低線量も用いられましたが,内分泌機能障害と知能の低下は避けられないと報告されています。逆に,これらの知見が髄芽腫の化学療法に対するやや過度の期待を高めたともいえます。
髄注MTX化学療法
髄芽腫の再発/再燃は髄液播種によって生じることが多いので,播種の予防と脳脊髄照射の負担を軽減するという理論的根拠で,髄腔内メソトレキセート注入による化学療法が使用されることがあります。しかし,現時点で播種を抑制できるという科学的根拠はありませんし,将来にわたっても相当の根拠がない限り,メソトレキセートような神経毒性のある薬剤は用いるべきではありません。治療後の認知機能低下がさらに悪化するからです。水溶性アルキル化剤マフォスファミドなどを用いる髄腔内化学療法が検討されましたが推奨するレベルの結果は出ませんでした 。
初発時に髄液播種を伴う症例に手術を行なわない
M2, M3の例であっても開頭手術による原発巣の積極的摘出が行なわれることが多いし標準治療法と言えます。病理確定診断も得られるからです。しかし,明らかな髄液播種がある症例では,いずれにしても高悪性度腫瘍であることに疑いはなく,いわゆる全摘出は不可能であり,また播種を放射線化学療法でコントロールできなければ生存の望みはありません。
従って,あえて開頭腫瘍摘出術というリスクを取らず,また放射線化学療法の開始を遅らせないためにも,画像診断後に髄液管理の長期留置型の体外ドレナージのみを設置して,化学療法あるいは脳脊髄照射から治療を開始する (neoadjuvant therapy) ことも有力な手段です。
画像診断で鑑別するべきものは,播種性格を有する上衣腫,退形成性上衣腫,AT/RT,PNET,毛様細胞性星細胞腫などですが,小脳の毛様細胞性星細胞腫が播種することは実際にはほとんどありません。他のいずれの腫瘍においても播種があれば脳脊髄照射は避け得ないものであり,また化学療法も類似のものが使用されます。髄芽腫以外のこれらの小脳原発悪性腫瘍は化学療法抵抗性である確率は高いのですが,1コースの低用量化学療法で感受性を見極めることから入ることもできるでしょうし,化学療法に抵抗性と判断されれば脳脊髄照射に移行できます。
原発巣が大きく初期の放射線化学療法で縮小しなければ,その時点で開頭腫瘍摘出術を考慮しても遅くはありませんし,播種もあり原発巣が巨大で,なおかつ放射線化学療法に反応しないという,その様な病態では手術適応もなく,緩和ケアをしたほうがいいという選択肢もあり得るものでしょう。
日本での方向性
上記の記述は全て欧米からの臨床試験報告であり日本国内には大規模な試験の報告はありません。小規模な共同研究は散見されますが,いずれのグループも信頼するに値するデータとしての無増悪5年生存割合を論文発表していません。日本の学会で,優れていると成果が強調されるのは初期成績 feasibility study ばかりであることを認識する必要があります。あるグループによるインターネット上での髄芽腫治療の喧伝も恥ずかしいことです。日本での共同研究を可能とするためには,まず全症例登録制を実現しなければ,今後も先が見えない状態が継続するのでしょう
髄芽腫においては,副作用がいかに高度であろうとも患児を治癒に導く最も有効な手段はいまだに放射線治療であることは確固たる事実です。化学療法の薬剤を選択し大量投与して放射線治療を省略しようとする過去の幾度かの試みは失敗に終わったことを記憶しておかなければなりません。
一方で,medulloblastoma with extensive nodularityのような病理所見を有する髄芽腫が,放射線治療を避けた大量化学療法のみで治癒することも知られて来ています。患児の年齢と病態によって,手術,放射線治療,化学療法を全て含めて,バランスよく最低限の侵襲手段で治療することがより求められる時です。いわゆるテイラーメイド治療ということになり,このことは逆に臨床研究の大きな妨げになるという矛盾をはらんで行きます。
生物学的基礎研究の進歩により,髄芽腫が放射線化学療法抵抗性であるか否かというという診断は,腫瘍細胞の発生起源と腫瘍増殖に関連する細胞内シグナル伝達の解明によって徐々に明らかになっています。また分子病理診断に基づき治療侵襲がテイラーメイドで選択可能な時代にもなってきているのでしょう。
過去の髄芽腫の分子標的治療のための研究
c-myc signaling
c-mycは癌遺伝子として広く知られています。c-Mycの過剰発現は髄芽腫においてもしばしば認められ,このc-myc遺伝子の活性化はSHHとWnt signalingの活性化によって生じるとされています。臨床的にはanaplastic / large cell medulloblastomaでの発現が知られ,ErbB2と同様に予後不良因子とされました。予後の悪いグループ3髄芽腫でMyc oncogene の高い発現があることが知られてきました。
さらに,histone deacetylase inhibitors (HDACIs) と phosphatidylinositol 3-kinase inhibitors (PI3KIs)が,MTC活性化髄芽腫に殺細胞効果があることが報告されました。panobinostat (HDACIsの一種)とPI3KIを併用する臨床試験が期待されています。
しかし,もしこれらの薬剤が難治性グループ3髄芽腫に効果があるとわかっても,それで”治癒”が得られるかは別問題で,なおかつものすごく高額な薬剤費となるでしょう。
nuclear accumulation of beta-catenin
細胞核でのbeta-catenin染色陽性が,予後良好な髄芽腫の病理組織マーカーとして有用であるとする報告がありました。 beta-cateninの細胞核集積はWnt (Wingless/Wg) signaling pathway の活性化と関連し,この経路に影響する遺伝子変異(beta-catenin, APC, AXIN2, survivin, SOX, CTNNB1)は多くの髄芽腫に検出されます。109髄芽腫症例のうち27例が核beta-catenin陽性であり,その5年全生存割合と無増悪生存割合は92%と89% であった,逆に核のbeta-catenin非染色例では,それぞれ65%と60%であり有意な差(p=0.0015, 0.0025)が認められたという報告があります。また注目すべきことに,核beta-catenin陽性例でありかつlarge cell medulloblastomaあるいは播種がある全ての症例が診断から5年の時点で生存していたとのことです。
sonic hedgehog (SHH) signalingとNotch signaling
SSH signalingは小脳の外顆粒層細胞の増殖を促すと考えられています。髄芽腫ではこのシグナル伝達に関与する遺伝子 (PTCH1, Smo) の異常が30%ほどに認められます。Notch signalingも小脳の顆粒層細胞の増殖に関与し,このシグナル伝達機構に関連する遺伝子の異常がある髄芽腫患者の予後は不良とする報告もあります。Wnt signaling, SHH signaling, Notch signaling pathwayはお互いに干渉しあう経路です。また,ErbB signalingはSHH signalingによって制御されています。これらの知見に未だに臨床的応用の具体性はありませんが,実験的にはSSH pathwayあるいはNotch pathwayを抑制することにより髄芽腫に対する分子標的治療の開発が期待されています。
ここに書いてあることと実際に澤村が行ってきたことの矛盾
開頭手術:髄芽腫の子供を診断したら,開頭手術による腫瘍摘出はなるべくしないようにして,化学療法と放射線治療で治療開始していました。世界標準は,髄芽腫を見つけたらまず開頭手術でできる限り摘出するということは知っています。また,私自身は小児の脳腫瘍の手術をとてもたくさん経験している脳外科医ですので大きく矛盾しています。理由は,初回手術によってM0のものをM1に進行させることになり,播種を誘発することを恐れていたからです。逆に,放射線と化学療法の後でも残った髄芽腫は,積極的に開頭手術で摘出していました。これは残存腫瘍があればそこから再発する確率が高いことは広く知られているからです,この根拠はあります。
化学療法:ICE化学療法は髄芽腫にとても効果(奏功割合)が高いです。1992年から使用していて現在でもまだ最も有効な化学療法のひとつだと考えています。限定的な成績は論文にも発表してありますし,かつての小児脳腫瘍の全国研究でも使用されていました。欧米でもこれとほぼ同様の化学療法は使用されていますので根拠はあります。しかし,パッカー先生たちの論文は権威が高いので,現時点ではあの化学療法が標準といわざるを得ません。小児の悪性腫瘍はすべてが標準治療で治療できるわけでもないのでしょうし,ある程度の根拠と実績に基づく治療は容認されるでしょう。しかし,思いつきの独自のユニークな化学療法は許される世界ではありません。
治療開始時期:多くの論文では,術後3週間くらいまでに補助療法の開始をするべきだと書いています。パッカー先生の論文では,31日以内に放射線治療を開始するとあります。でも1992年頃から私は,髄芽腫と診断したら即刻,その日のうちにでも手術摘出して,術後1週間くらいまでには化学療法あるいは放射線治療を開始してきました。病理は凍結標本でみて確定診断前に補助療法を開始したことが多いです。また,2000年以降では積極的には開頭手術をしなかったので,髄芽腫と画像診断したら1週間以内くらいに化学療法を開始 (neoadjuvant therapy) して,放射線治療はさまざまに組み合わせていました。
文献
- Ashley DM, et al.: Induction chemotherapy and conformal radiation therapy for very young children with nonmetastatic medulloblastoma: Children’s Oncology Group study P9934. J Clin Oncol. 30:3181-3186, 2012
- Atalar B: Treatment outcome and prognostic factors for adult patients with medulloblastoma: The Rare Cancer Network (RCN) experience. Radiother Oncol. 2018
- Blaney SM, Boyett J, Friedman H, et al: Phase I clinical trial of mafosfamide in infants and children aged 3 years or younger with newly diagnosed embryonal tumors: a pediatric brain tumor consortium study (PBTC-001). J Clin Oncol 23:525-533, 2005
- Blüml S, et al.: Molecular subgroups of medulloblastoma identification using noninvasive magnetic resonance spectroscopy. Neuro Oncol 2015 [Epub], 2015
- Cabdelbaki MS, et al; Desmoplastic Nodular Medulloblastoma in Young Children: A Management Dilemma. Neuro Oncol 2017
- Cajjar A , et al: Risk-adapted craniospinal radiotherapy followed by high-dose chemotherapy and stem-cell rescue in children with newly diagnosed medulloblastoma (St Jude Medulloblastoma-96): long-term results from a prospective, multicentre trial. Lancet Oncol 2006 Oct;7(10):813-20
- Chi SN, Gardner SL, Levy AS, et al: Feasibility and response to induction chemotherapy intensified with high-dose methotrexate for young children with newly diagnosed high-risk disseminated medulloblastoma. J Clin Oncol 22:4881-4887, 2004
- de Bont et al: Biological bachground of pediatric medulloblastoma and ependymoma: a review from a transitional reserch perspective. Neuro-Oncol 10: 1041-1060, 2008
- Ellison DW, Onilude OE, Lindsey JC, et al: beta-Catenin status predicts a favorable outcome in childhood medulloblastoma: the United Kingdom Children’s Cancer Study Group Brain Tumor Committee. J Clin Oncol 23: 7951-7957, 2005
- Fouladi M, Gajjar A, Boyett JM, et al.: Comparison of CSF cytology and spinal magnetic resonance imaging in the detection of leptomeningeal disease in pediatric medulloblastoma or primitive neuroectodermal tumor. J Clin Oncol 17: 3234-3237, 1999
- Fouladi M, Chintagumpala M, Laningham FH, et al: White matter lesions detected by magnetic resonance imaging after radiotherapy and high-dose chemotherapy in children with medulloblastoma or primitive neuroectodermal tumor. J Clin Oncol. 2004 Nov 15;22(22):4551-60
- Gajjar A, et al: Clinical, histopathologic, and molecular markers of prognosis: toward a new disease risk stratification system for medulloblastoma. J Clin Oncol 22:971-974, 2004
- Grill J et al.: Preoperative chemotherapy in children with high-risk medulloblastomas: a feasibillity study. J Neurosurg (Pediatrics 4) 103: 312-318, 2005
- Grill J, et al.: Phase II study of irinotecan in combination with temozolomide (TEMIRI) in children with recurrent or refractory medulloblastoma: a joint ITCC and SIOPE brain tumor study. Neuro Oncol 15:1236-1243, 2013
- Hallahan AR, et al: The SmoA1 mous model reveals that notch signaling is critical for the growth and survival of sonic hedgehog-induced medulloblastomas. Cancer Res 64: 7794-7800
- HIT-MED study centre, HIT-MED Guidance for Patients with newly diagnosed Medulloblastoma, Ependymoma, CNS Embryonal Tumour, and Pineoblastoma. 2017
- Hoppe-Hirsch E, Renier D, Lellouch-Tubiana A, et al: Medulloblastoma in childhood: progressive intellectual deterioration. Childs Nerv Syst 6:60-65, 1990
- Jakacki RI, Feldman H, Jamison C, et al: A pilot study of preirradiation chemotherapy and 1800 cGy craniospinal irradiation in young children with medulloblastoma. Int J Radiat Oncol Biol Phys 60:531-536, 2004
- Jakacki RI, et al.: Outcome of children with metastatic medulloblastoma treated with carboplatin during craniospinal radiotherapy: a Children’s Oncology Group Phase I/II study. J Clin Oncol 30: 2648-2653, 2012
- Kann BH, et al.: Postoperative Radiotherapy Patterns of Care and Survival Implications for Medulloblastoma in Young Children. JAMA Oncol 2016
- Efficacy of Carboplatin and Isotretinoin in Children With High-risk MedulloblastomaA Randomized Clinical Trial From the Children’s Oncology Group. JAMA Oncol 2021
- Morrissy AS, et al.: Divergent clonal selection dominates medulloblastoma at recurrence. Nature 529, 351–357, 2016
- Moxon-Emre I et al.: Impact of Craniospinal Dose, Boost Volume, and Neurologic Complications on Intellectual Outcome in Patients With Medulloblastoma J Clin Oncol [Epub], 2014
- Mulhern RK, Kepner JL, Thomas PR, et al.: Neuropsychologic functioning of survivors of childhood medulloblastoma randomized to receive conventional or reduced-dose craniospinal irradiation: a Pediatric Oncology Group study. J Clin Oncol 16: 1723-1728, 1998
- Northcott PA, et al.: Medulloblastoma comprises four distinct molecular variants. J Clin Oncol 29: 1408-1414, 2010
- Northcott PA, et al.: Subgroup-specific structural variation across 1,000 medulloblastoma genomes Nature 488: 49-56, 2012
- Northcott PA, et al.: The whole-genome landscape of medulloblastoma subtypes. Nature 547, 2017
- Packer RJ, Sutton LN, Elterman R, et al.: Outcome for children with medulloblastoma treated with radiation and cisplatin, CCNU, vincristine chemotherapy. J Neurosurg, 81: 690-698, 1994
- Packer RJ, Goldwein J, Nicholson HS, et al.: Treatment of children with medulloblastomas with reduced-dose craniospinal radiation therapy and adjuvant chemotherapy : A Children’s Cancer Group Study. J Clin Oncol 17; 2127-2136, 1999
- Palmer SL, et al.: Processing speed, attention, and working memory after treatment for medulloblastoma: an international, prospective, and longitudinal study. J Clin Oncol 31: 3494-3500, 2013
- Oyharcabal-Bourden V et al.: Standard-risk medulloblastoma treated by adjuvant chemotherapy followed by reduced-dose craniospinal radiation therapy. J Clin Oncol 23: 4726-4734, 2005
- Packer RJ: Medulloblastoma. J Neurosurg (Pediatrics 4) 103: 299-301, 2005
- Packer RJ, et al.: Phase III study of craniospinal radiation therapy followed by adjuvant chemotherapy for newly diagnosed average-risk medulloblastoma. J Clin Oncol 24: 4202-4208, 2006
- Patay Z, et al.: MR Imaging Characteristics of Wingless-Type-Subgroup Pediatric Medulloblastoma. AJNR Am J Neuroradiol 36: 2015
- Remke M, et al.: FSTL5 Is a Marker of Poor Prognosis in Non-WNT/ Non-SHH Medulloblastoma. J Clin Oncol. 2011 Sep 12. [Epub ahead]
- Ris MD, Packer R, Goldwein J, et al: Intellectual outcome after reduced-dose radiation therapy plus adjuvant chemotherapy for medulloblastoma: a Children’s Cancer Group study. J Clin Oncol 19: 3470-3476, 2001
- Robinson G, et al.: Risk-adapted therapy for young children with medulloblastoma (SJYC07): therapeutic and molecular outcomes from a multicentre, phase 2 trial. Lancet Oncol 2018
- Romer JT, et al: Suppression of the Shh pathway using a small molecule inhibitor eliminates medulloblastoma in Ptc1(+/-)p53(-/-) mice. Cancer Cell 6: 229-240, 2004
- Rutkowski S, et al.: Treatment of early childhood medulloblastoma by postoperative chemotherapy alone. N Engl J Med. 2005 Mar 10;352: 978-86, 2005
- Rutkowski S, et al.: Treatment of early childhood medulloblastoma by postoperative chemotherapy and deferred radiotherapy. Neuro Oncol. 2009
- Schmahmann JD: Pediatric post-operative cerebellar mutism syndrome, cerebellar cognitive affective syndrome, and posterior fossa syndrome: historical review and proposed resolution to guide future study. Childs Nerv Syst. 2019
- Sethi RV, et al.: Patterns of failure after proton therapy in medulloblastoma; linear energy transfer distributions and relative biological effectiveness associations for relapses. Int J Radiat Oncol Biol Phys 88: 655-63, 2014
- Shih DJ, et al.: Cytogenetic prognostication within medulloblastoma subgroups. J Clin Oncol 32: 886-896, 2014
- Sands SA: Helping survivors of medulloblastoma learn from what we learn. J Clin Oncol 31:3480-3482, 2013
- Schwalbe EC, et al.: Novel molecular subgroups for clinical classification and outcome prediction in childhood medulloblastoma: a cohort study. Lancet Oncol 2017
- Spiegler BJ, Bouffet E, Greenberg ML, et al.: Change in neurocognitive functioning after treatment with cranial radiation in childhood. J Clin Oncol. 2004 Feb 15;22(4):706-13
- Stearns D, et al.: c-Myc overexpression causes anaplasia in medulloblastoma. Cancer Res 66: 673-681, 2006
- Strother DR, et al.: Feasibility of four consecutive high- dose chemotherapy cycles with stem cell rescue for patients with newly diagnosed medulloblastoma or supratentrial primitive neuroectodermal tumor after craniospinal radiotherapy: results of a collaborative study. J Clin Oncol 19; 2696- 704, 2001
- Strother DR, et al.: Benefit from prolonged dose-intensive chemotherapy for infants with malignant brain tumors is restricted to patients with ependymoma: a report of the Pediatric Oncology Group randomized controlled trial 9233/34. Neuro Oncol 16: 457-65, 2014
- Taylor RE , et al: International Society of Paediatric Oncology; United Kingdom Children’s Cancer Study Group : Results of a randomized study of preradiation chemotherapy versus radiotherapy alone for nonmetastatic medulloblastoma: The International Society of Paediatric Oncology/United Kingdom Children’s Cancer Study Group PNET-3 Study. J Clin Oncol 21:1581-1591, 2003
- Taylor RE, et al: Outcome for patients with metastatic (M2-3) medulloblastoma treated with SIOP/UKCCSG PNET-3 chemotherapy. Eur J Cancer. 2005 Mar;41(5):727-34
- Wechsler-Rena RJ, et al: Controle of neuronal precursor proliferation in the cerebellum by sonic hedgehog. Neuron 22: 103-114, 1999
- The Committee of Brain Tumor Registry of Japan: Special report of Brain Tumor Registry of Japan (1969-1996). Neurol Med Chir (Tokyo), 43: 5-26, 2003
- Thomas PR, Deutsch M, Kepner JL, et al.: Low-stage medulloblastoma: final analysis of trial comparing standard-dose with reduced-dose neuraxis irradiation. J Clin Oncol 18: 3004-3011, 2000
- von Bueren AO, et al.: Treatment of young children with localized medulloblastoma by chemotherapy alone: results of the prospective, multicenter trial HIT 2000 confirming the prognostic impact of histology. Neuro Oncol 13: 669-679, 2011
- von Bueren AO, et al.: Treatment of Children and Adolescents With Metastatic Medulloblastoma and Prognostic Relevance of Clinical and Biologic Parameters. J Clin Oncol 2016
- Zeltzer PM, Boyett JM, Finlay JL, et al.: Metastasis stage, adjuvant treatment, and residual tumor are prognostic factors for medulloblastoma in children: conclusions from the Children’s Cancer Group 921 randomized phase III study. J Clin Oncol 17: 832-845, 1999